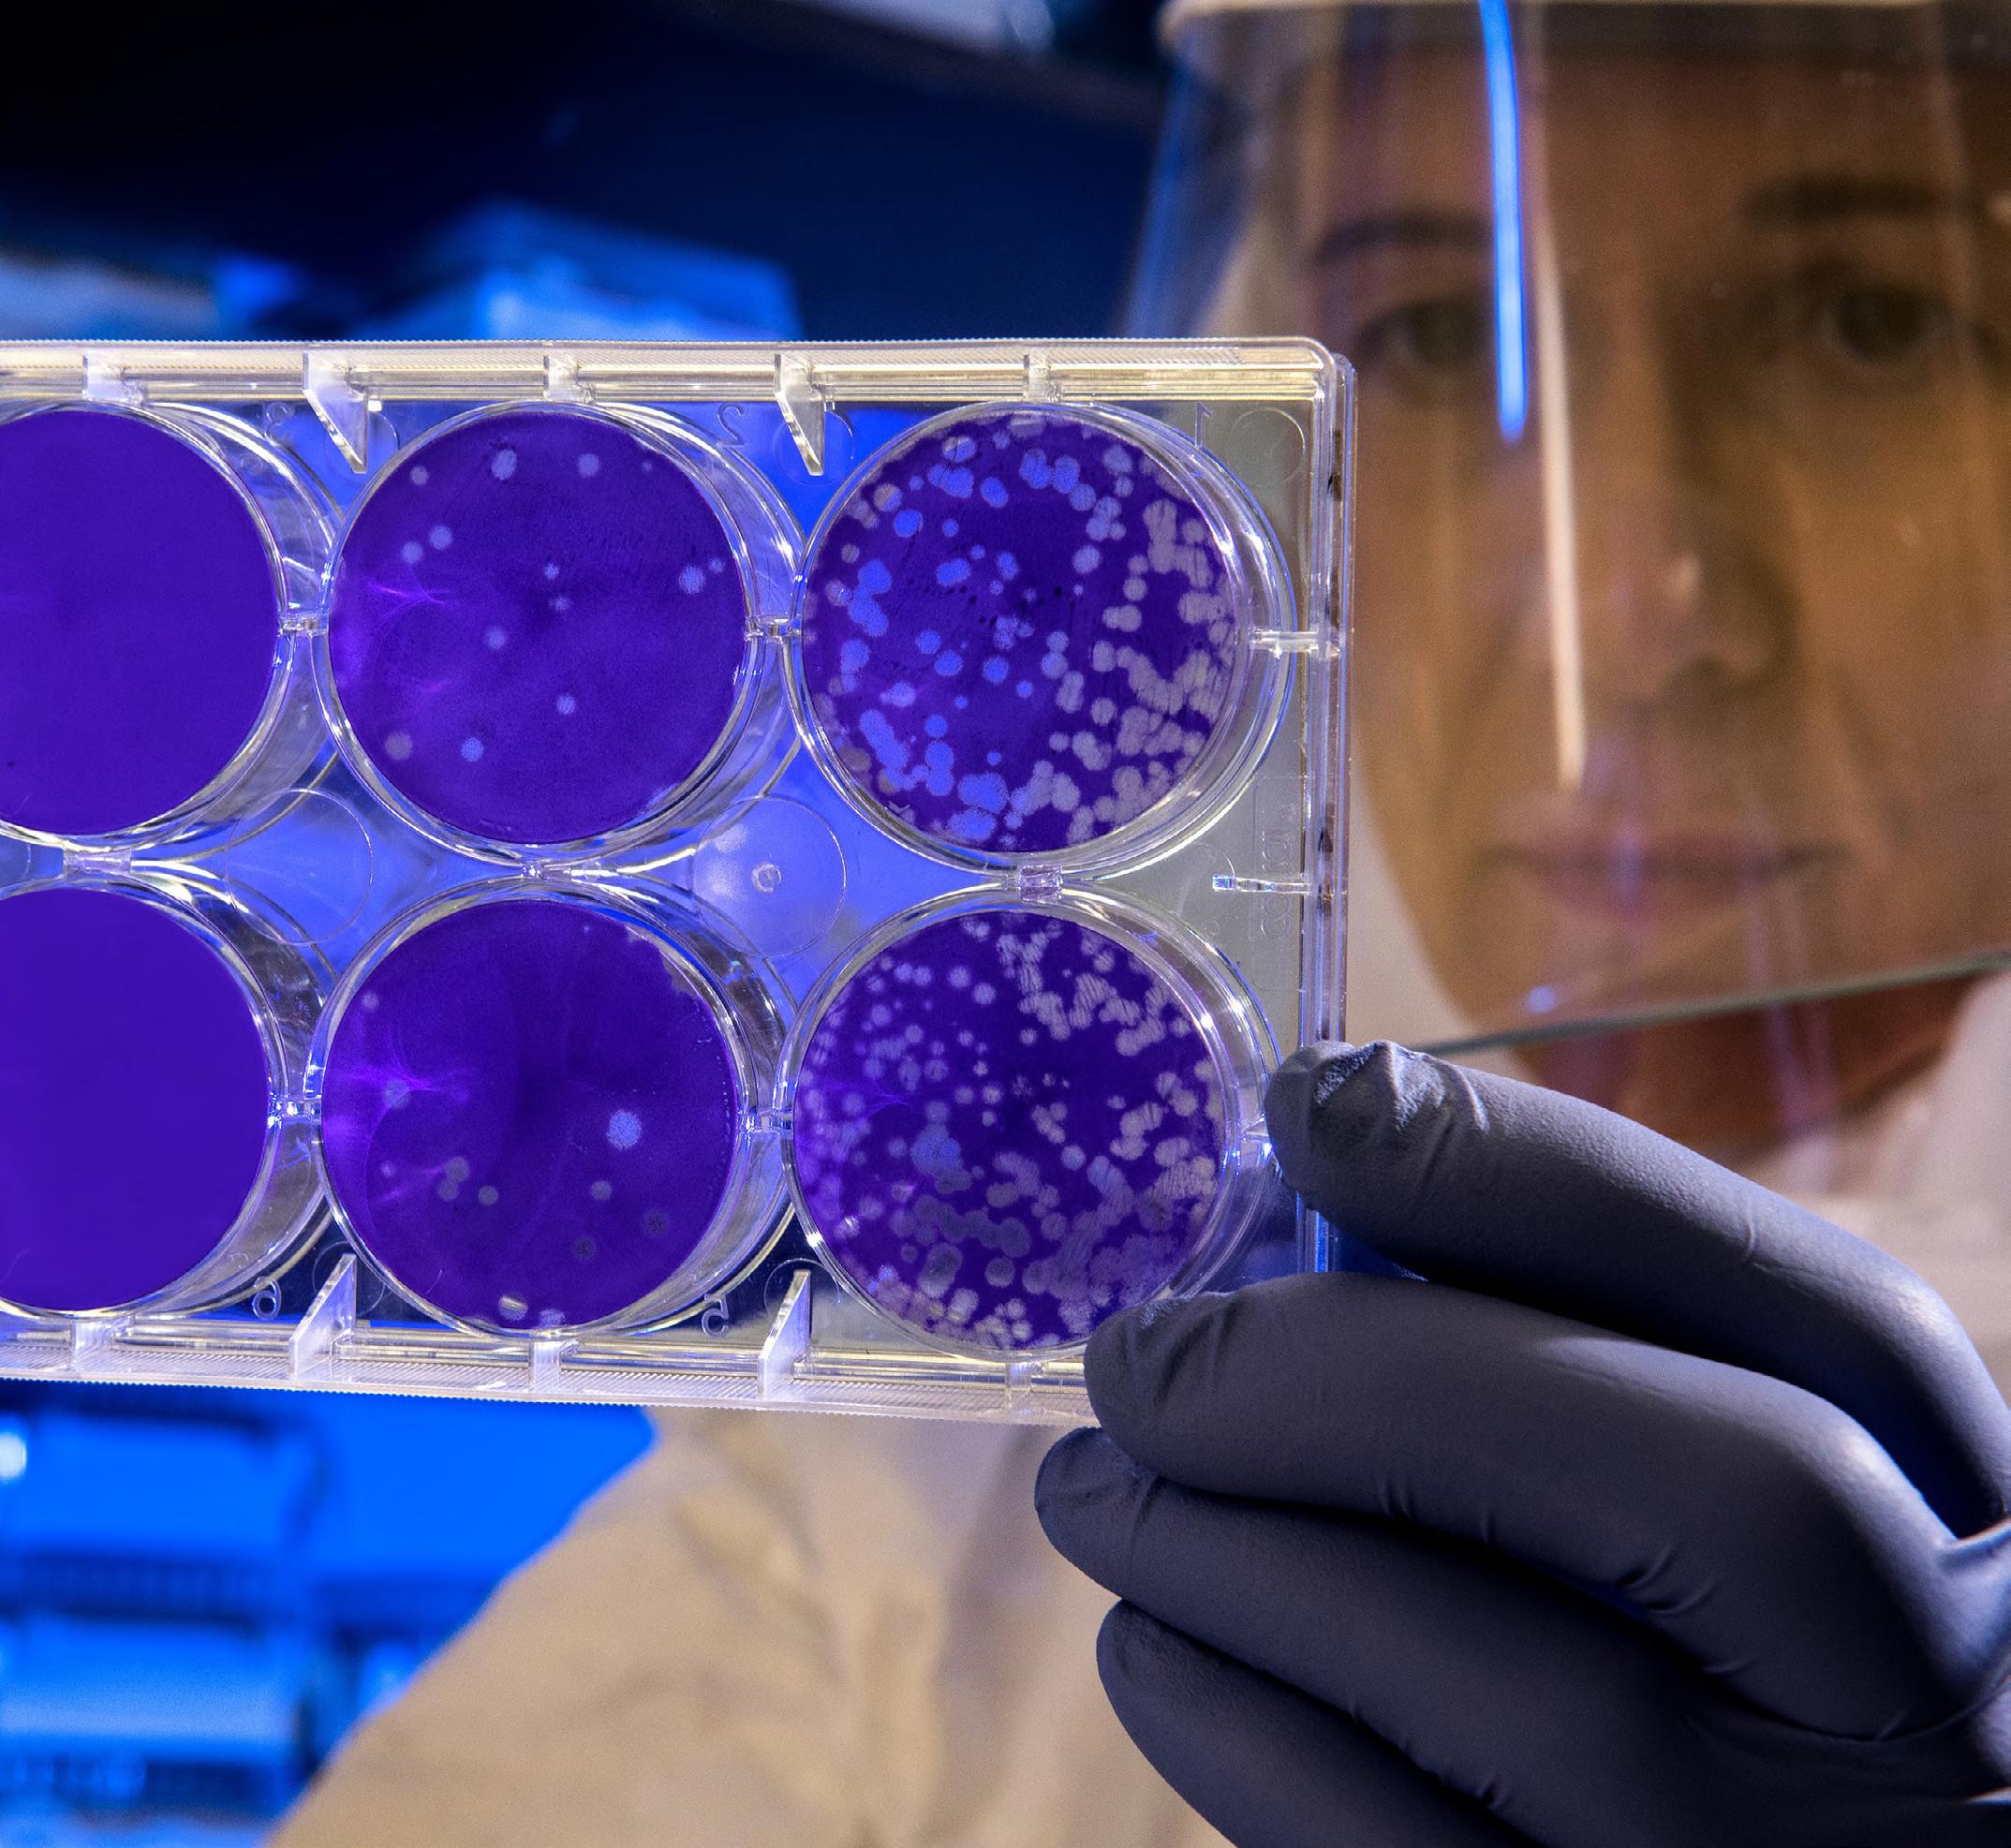

DIRECTOR: Mark A. Barker
INTERNATIONAL MEDIA DIRECTOR: Anthony Stewart anthony@senglobalcoms.com
EDITORIAL MANAGER: Beatriz Romao beatriz@senglobalcoms.com
DESIGN DIRECTOR: Jana Sukenikova www.fanahshapeless.com
FINANCE DEPARTMENT: Akash Sharma accounts@senglobal.co.uk
RESEARCH & CIRCULATION: Jessica Chapman jessica@senglobalcoms.com
COVER IMAGE: iStockphoto ©
PUBLISHED BY: Senglobal ltd. Unit 5.02, E1 Studios, 7 Whitechapel Road, E1 1DU, United Kingdom
Tel: +44 (0)20 4541 7569 Email: info@senglobalcoms.com www.international-biopharma.com
All rights reserved. No part of this publication may be reproduced, duplicated, stored in any retrieval system or transmitted in any form by any means without prior written permission of the Publishers.
The next issue of IBI will be published in Winter 2022.
ISSN No.International Biopharmaceutical Industry ISSN 1755-4578.
The opinions and views expressed by the authors in this journal are not necessarily those of the Editor or the Publisher. Please note that although care is taken in the preparation of this publication, the Editor and the Publisher are not responsible for opinions, views, and inaccuracies in the articles. Great care is taken concerning artwork supplied, but the Publisher cannot be held responsible for any loss or damage incurred. This publication is protected by copyright.
2022 Senglobal ltd. Volume 5 Issue 3 – Autumn 2022
Establishing a foundation for proactive quality requires taking a cross-functional view of processes and documentation and then streamlining and standardising them. Some are starting efforts in the QC lab and with validation. Robert Gaertner at Veeva Vault Quality will focus on two critical areas that are receiving more attention: improving quality control laboratories, processes, and systems and establishing paperless validation management.
According to Retraction Watch, over 250 papers regarding COVID-19 published since the start of the pandemic have since been retracted. While retractions are an acknowledged necessity for academic journals, the growing justifications demand attention. Much focus is concentrated on checking the text of manuscripts, but in the digital age images are often more important when conveying results to readers. Dr. Dror Kolodkin-Gal at Proofiger Ltd. discusses the importance of image integrity and common sources of issues.
There is growing excitement about the potential shown by cell and gene therapies, particularly in rare diseases. First, though, these therapies face challenges both in development and in aligning to regulatory guidance that was established long before the advent of advanced therapeutic medicinal products (ATMPs). Francesco Lanucara at PharmaLex explores the challenge of navigating guidelines that don’t always reflect the complexity of ATMPs and the importance of achieving regulatory convergence across different regions.
Extractable and leachable studies on primary packaging systems are well established in the pharmaceutical industry. For extraction studies, guidelines and best practice guides mandate a worst-case approach, taking the active, the formulation and the container closure system into account. However, an assessment of the proteinreactivity of extractables are not in the scope of standard extraction procedures. André Stratman, et al at A&M Stabtest discusses a proposed modification of the protein-reactivity screening, by adding an electrochemical oxidation step, to not only evaluate extractables, but to also see, if there is a subset of extractables, which oxidized derivatives have protein reactive properties.
Since May 2022, Medicilon has successfully assisted no less than ten ADC drugs on their path to approval for clinical use, and it’s committed to continuously improving the research capabilities of ADC drugs. As a matter of fact, half of these drugs target the protein HER2 (human epidermal growth factor receptor 2), member of the HER family of membrane tyrosine kinases, developed for many years as an important target in breast cancer treatment. The design idea of the ADC drugs is to couple antibodies with cytotoxic drugs, to simultaneously exert the high specificity of antibodies and the high toxicity of cytotoxic small molecules. The emergence
www.international-biopharma.com
of ADC drugs fills the gap between antibody drugs and traditional chemotherapeutic drugs, increasing the specificity of drugs and improving the therapeutic window.
The pandemic laid bare inefficiencies and vulnerabilities across laboratory operations where global supply chain issues, alongside high testing volumes, and the demand for faster turn-around-times disrupted the pace of innovation and productivity. May Huxley and Robin Aris at Synergy explore new innovative models in scientific services are helping laboratory operations advance, while minimising risk and returning time back to science.

The biologic market has grown expediently over the past few years, driven not only by the pandemic but also by the increasing demand for innovative therapies, the continued rise in chronic disease areas such as oncology and the loss of patent exclusivity of leading biologic drugs. That has led to rapid growth of aseptic processing, which is expected to reach $24.36 billion by 2031, growing from $10.63 billion in 2020, witnessing a CAGR of 7.9% (2021–2031). Tom McGrath at PCI Pharma Services notes that with the pharmaceutical industry’s growing pipeline of biologics, the need for technically advanced manufacturing and specialized packaging support has grown considerably.
The delivery of therapeutics by inhalation is a medical process dating back thousands of years. The first written evidence of this can be found ca. 1550 BC in Egypt, where vapours of the black henbane plant were used to treat patients with breathing difficulties. We now know this vapour likely contained anticholinergic chemicals similar to those now used in modern inhalers to reduce inflammation and bronchoconstriction in the airways. Despite major advances over the past three millennia in the treatment of pulmonary disease patients with inhaled medications, there is still no single therapy that controls the underlying lung disease, only temporary, symptom management-based approaches. Emily Richardson at CN Bio Innovations outlines the future of inhaled medication testing.
The development of lyophilised products helps reduce the impact of cold chain management from refrigerated warehouse to point use. These products, typically, benefit from lower shipping costs, simplify product use, and provide a longer shelf life within the diagnostics, biologics, pharmaceuticals and nutraceutical industries. Biopharm Group explains the importance of Lyobeads and using the MicroPress to determine quality metrics.
are Scientific Protein Laboratories.




over
years of expertise in development and cGMPcompliant manufacturing,
have become a trusted global source for innovation, customization, and

manufacturing of high quality
Custom process development
supply chain
naturally derived pharmaceutical
I am particularly pleased to see the that this issue features an article about antibody-drugconjugates and to have Medicilon sharing their experience in the ADC field. The development of ADCs is a complex business The production and QC analysis of monoclonal antibodies alone is challenging, but the addition of a suitable linker and toxin payload to the antibody, adds to the complexity. Identifying CDMOs capable of handling ADCs is another challenge. As many CMOs for antibody production are not necessarily particularly experienced in the CMC aspects of drug conjugation, let alone have the capability of handling highly potent toxins.
Complex molecules like ADCs, may require the implementation of different production sites and QC laboratories often located on different continents. This poses challenges in managing the overall quality of these products. Therefore, it is important to implement proactive quality management systems to improve and streamline processes and systems early on. A key feature of successful multi-site operation is to have paperless systems in place. Robert Gaertner gives an insight into the systems offered by Veeva Vault Quality to overcome these challenges and his expertise in implementing proactive quality management systems.
The COVID-19 pandemic has taught us all lessons about the vulnerability of supply chains of, products and materials our lives and businesses depend on, but also on the supply and integrity of reliable scientific information.
In times where information can be distributed to a global audience with a tap on a screen it becomes increasingly difficult, to scrutinize information for its accuracy and authenticity. Images and figures conveying scientific information need to be accurate and unambiguous, so that cannot be taken out of context support “alternative” narratives. Dr. Dror Kolodkin-Gal from Proofiger Ltd talks about the importance of image integrity and why we should not only scrutinize scientific texts but also images and figures.
Laboratories around the world are still facing a disruption of supplies. In the past months many organizations had to spend
• Ashok K. Ghone, PhD, VP, Global Services MakroCare, USA
• Bakhyt Sarymsakova – Head of Department of International Cooperation, National Research Center of MCH, Astana, Kazakhstan
• Catherine Lund, Vice Chairman, OnQ Consulting
• Cellia K. Habita, President & CEO, Arianne Corporation
• Chris Tait, Life Science Account Manager, CHUBB Insurance Company of Europe
• Deborah A. Komlos, Senior Medical & Regulatory Writer, Clarivate Analytics
• Elizabeth Moench, President and CEO of Bioclinica – Patient Recruitment & Retention
• Francis Crawley, Executive Director of the Good Clinical Practice Alliance – Europe (GCPA) and a World Health Organization (WHO) Expert in ethics
• Hermann Schulz, MD, Founder, PresseKontext
• Jim James DeSantihas, Chief Executive Officer, PharmaVigilant
considerable resources to mitigate or overcome shortcomings of supplies by either finding alternative sources or implementing stocks. Many organizations found that dealing with these situations disrupted or delayed necessary innovation and productivity. May Huxley and Robin Aris at Synergy explore new models in scientific services to regain lost resources to advance lab operations and scientific innovation.
The first available COVID vaccinations brought to light how drug supply and global availability is influenced by defined storage and shipping condition. Therefore, the handling conditions of a drug should be addressed early on in development and therefore finding ways to enhance thermal stability e.g. by lyophilization should be explored. Defining the right conditions to ensure consistent quality of lyophilizates is challenging. XXXX at Biopharm highlights how Lyobeads and MicroPress can help to determine quality metrics.
The efficient co-development of a pharmaceutical formulation and application device is key to the success of inhalable drug development. To support the development process fast access to analytical data about aerodynamic particle size distribution, delivered dose and dose variability is important. Emily Richardson of CN Bio Innovations shares her insight on the future of inhaled medication testing.
Recent advances in cell and gene therapies offer a chance to not only treat but cure diseases like cancer or even genetic disorders. These revolutionary treatments will force pharmaceutical companies, clinics and regulators to partly redefine the quality rule book. But in the meantime Francesco Lanucara at PharmaLex can offer some guidance on how to play by the rules initially defined for small molecule and biomoleculebased drugs.
Lastly, A&M STABTEST proposes a novel approach to simulate aging-related effects on extractables to evaluate their potential for future protein reactivity.
Dr. Steven A. Watt, Head of Business Development at A&M STABTEST GmbH• Jeffrey W. Sherman, Chief Medical Officer and Senior Vice President, IDM Pharma.
• Lorna. M. Graham, BSc Hons, MSc, Director, Project Management, Worldwide Clinical Trials
• Mark Goldberg, Chief Operating Officer, PAREXEL International Corporation
• Maha Al-Farhan, Chair of the GCC Chapter of the ACRP
• Rick Turner, Senior Scientific Director, Quintiles Cardiac Safety Services & Affiliate Clinical Associate Professor, University of Florida College of Pharmacy
• Robert Reekie, Snr. Executive Vice President Operations, Europe, Asia-Pacific at PharmaNet Development Group
• Stanley Tam, General Manager, Eurofins MEDINET (Singapore, Shanghai)
• Stefan Astrom, Founder and CEO of Astrom Research International HB
• Steve Heath, Head of EMEA – Medidata Solutions, Inc


We are a global Contract Testing Development and Manufacturing Organization (CTDMO) providing strategic partnership to cell and gene therapy pioneers
Your single supplier from discovery to commercialization
Work with us to accelerate your time to market
Advanced technologies, manufacturing and testing solutions
Promoter and capsid optimization and cell line development
Custom and off-the-shelf plasmid manufacture and supply
Optimized platforms for viral vector and cell therapy manufacture
analytical development and testing services
Regulatory support packages
To view more,
More organisations have adopted modern quality systems to move beyond manual and paper-based processes. However, a recent survey found that nearly half of companies that were modernising their quality management practices still had limited ability to use data for proactive quality management.1 More foundational work will be needed if the industry is to harness the power of automation, predictive analytics, and artificial intelligence (AI) for trending and improved decisionmaking.
The first step in this work is to assemble cross-functional teams to analyse processes from different user perspectives and standardise them. This article will focus on two critical areas that are receiving more attention: improving quality control laboratories, processes, and systems and establishing paperless validation management.
As part of incremental efforts to improve QC lab efficiency over the years, quality leaders at many companies installed different point applications to optimise specific outcomes. Over time, this resulted in a situation where each lab, even those within the same organisation or facility, was using different tools with different logins, making it difficult to find, share, and report on data with colleagues in other divisions. Disconnected workflows left companies ill-prepared to keep pace with evolving business needs. Given the importance of QC to business goals, focusing foundational work in this area alone can significantly impact business results.
To develop more agile digital laboratories, QC leaders whose systems have become disconnected will need to reimagine an approach that advances a connected quality ecosystem. This requires thinking beyond specific tools and problems to consider a holistic approach to modernising QC and how it will fit within the organisation's overall technology modernisation efforts.
Before considering potential technology solutions, quality leaders need to evaluate the problem carefully and from different points of view. Accomplishing this goal will require a cross-functional team whose daily work processes depend on quality data to develop the best approaches for resolving it. The team will eliminate bias by considering processes within a broader cross-functional context. Together, members can consider such questions as whether standards might be used to organise work processes or whether procedures might be combined or improved.
For this challenge, a comprehensive solution based on a single technology platform could streamline sample management and lab investigation processes and decrease inventory expenses.
It could also bring QC and QA processes closer together, streamlining lab operations for faster batch release.
However, selecting technology should formally start only after the team has analysed the problem in depth from different perspectives. In this case, the need for connectivity should drive analysis and consideration of potential solutions.
QC operations usually include manual processes that depend on paper, spreadsheets, homegrown systems or vendor point solutions. First, the cross-functional team needs to take a step back and evaluate the complete quality ecosystem. The team should ask how multiple business processes could be improved and then map out processes end-to-end to determine what activities or systems can be streamlined. Looking at lab issues holistically is key to more effective overall results.
It’s never too early to think about change management because technology users do not accept will never result in change. Assemble another team across functions to lead the strategy for change management, prioritise efforts, and keep projects on track. Leverage vendor services and consulting firms for expertise that strengthens the initiative. A committee with internal leaders, quality experts, and third-party partners can deliver the right combination of people to drive a successful transformation.
To move the conversation forward toward technology selection, design a matrix that includes current and future needs, as well as new and existing products, services, and support. The ultimate goal should be driving more connection and collaboration throughout quality and manufacturing.
When deciding on the systems that will support this initiative, consider 24/7 access to data, seamless information sharing, and the user experience and interface. Solutions that provide connectivity via open APIs enable easy integration with existing systems, simplifying information sharing across teams.
In a typical scenario, team members must use different logins to different systems to upload, download, and share files with various departments. Through modernisation efforts, users will gain a unified document repository, creating a single source of truth and eliminating the pain points associated with multiple logins and screens.
Ultimately, taking this approach, and focusing on one problem, empowers quality leaders to drive change while up-levelling the entire QC environment.
Managing validation projects is an area in need of innovation and advances efforts to enable proactive quality management.

Historically, using paper-based processes for validation management has led to unreliable data and questionable results. A rise in regulatory citations for data integrity violations is driving change in the industry, including regulatory guidance that re-emphasises the need for compliance with current good manufacturing practices (cGMPs).
More companies are establishing a path to streamlined validation by enabling paperless process execution. To do so, the industry will need regulatory support and alignment, best practices and guides, and advanced applications.
Regulations emphasise the need to prioritise data integrity throughout the cGMP data lifecycle across the creation, modification, processing, maintenance, archival, retrieval, transmission, and disposition of data.2 Digital tools make detecting unusual results, errors, or omissions easier and faster, especially compared to older IT systems.
Moving to digital validation management will streamline processes such as organising validation activities, managing a global library of test scripts, and digitally executing protocols. Faster and more efficient validation projects will lead to robust data-collection practices in the short and long term. Built on a solid foundation of quality data, the result is improved audit and inspection readiness.
Industry standards can also help prioritise data integrity efforts while driving standardisation. In cases where using specific industry standards isn't possible, some modern cloud technology solutions offer embedded best practices so that quality leaders don’t recreate old processes in a new environment.
The following best practices can help your organisation advance validation transformation:
1. Bring cross-functional stakeholders into the project early to ensure that needs are met across teams.
2. Create and share the validation vision and process to identify what needs to be done. Consider integrated systems, applications, facilities, utilities, and equipment.
3. Create a global governance team to oversee the management of templated validation content before implementing a digital validation solution.
4. Evaluate technologies such as flexible, cloud-based solutions that meet your organisation's requirements against industry best practices. Explore solutions that enable different experiences based on user level throughout the validation lifecycle and accommodate both on- and off-site support.
5. Integrate ongoing change management, including training and support. Consider a phased approach to avoid overwhelming teams adjusting to new processes.
As outsourcing continues transforming pharma manufacturing, more large pharma companies have included their contract
partners in quality modernisation efforts. One company, which counts on contract partners for about 70% of its output, used cloud-based quality applications to onboard all manufacturing partners and collaboratively author product specs, quality agreements, and other critical documents. It also implemented a compliant digital archive of validation records. Contract development and manufacturing organisations (CDMOs) are also establishing their own foundation for process consistency and compliance using modern quality systems. To support these efforts, regulators emphasise the need to bring quality metrics into day-to-day operations, while pharma companies adopt an organisation-wide quality mindset. This includes reducing variability in their processes and taking a proactive approach to quality as an enabler of operational excellence.3 As a result, some companies benefit from process improvements and use quality as a strategic asset rather than a cost center.
The ability to deliver consistent product quality has emerged as an essential differentiator. Organisations that leverage data-driven techniques achieve better control over manufacturing processes, whether handled internally or through a CDMO.
The industry’s goal is to accelerate discovery and access to new therapies and improve patient outcomes. Digital cloud technology can help make this happen by bringing together departments, systems, teams, and geographies. Robust technology that leverages and encourages industry standards, automates processes, and meets regulatory requirements, offers a path from reactive to proactive quality management.
However, the proper foundation must first be established, with a cross-functional view and seamless, standardised processes. How you get to that foundation via localised projects or a ‘big bang’ effort is up to you, but once you do, powerful tools are there to automate processes and bring more insights from quality data to improve business results.
Systems, Enabling Proactive Quality Management Webinar,
for Industry, Data Integrity and Compliance with Drug CGMP, (CDER, CBER, and CVM),
of St. Gallen, 2020 Quality Benchmarking Study, 2020
Robert is Veeva's senior director of strategy for quality in Europe. With more than 20 years of experience in the life sciences industry, he has a deep understanding of processes and systems in GxP-related areas. After starting his industry career at Fresenius Kabi, Robert led various large programs implementing quality-related systems, including eDMS, eQMS and LIMS at different customers in pharma, biotech, and medtech. As a subject matter expert and industry consultant, he has worked for leading companies such as PwC Consulting, IBM, Lodestone, and Infosys.


According to Retraction Watch, over 250 papers regarding COVID-19 published since the start of the pandemic have since been retracted. While retractions are an acknowledged necessity for academic journals, the growing justifications demand attention. Much focus is concentrated on checking the text of manuscripts, but in the digital age images are often more important when conveying results to readers. Here, Dr. Dror Kolodkin-Gal, founder of automated image integrity checking software Proofiger Ltd., discusses the importance of image integrity and common sources of issues.
According to the STM Global Brief 2021 – Economics and Market Size report, the global science, technology and medical publishing market was worth 26.5 billion USD in 2020. Scientific research papers are seen as the gold standard for increasing our understanding of the world. Given the high regard in which academia is held, along with the growing size of the publishing market, the importance of maintaining the integrity of the industry is unquestionable. It is vital for the industry to ensure that findings and methodology are kept to rigorous standards to prevent reader misinterpretation and maintain credibility.
Retractions and amendments have always been a part of academic publishing, especially considering the recognised notion that science is self-correcting. However, according to the previously mentioned report, roughly 48,000 scholarly peer-reviewed journals are published yearly. Furthermore, the recent surge in misinformation, particularly involving COVID-19 and vaccines, reaching public opinion as well as steady retraction rates, it has highlighted an important issue – that the review process must be modernised.
Scientific image integrity covers a broad scope, with different journals holding unique guidelines for ensuring integrity. Recent developments, such as the joint guidelines issued by representatives from eight publishers in late 2021, offered detailed information for specific scenarios. The three categories listed covered scenarios where some images have been altered or beautified whilst avoiding affecting the research’s conclusions, to level three which involved “severe manipulation”. Each category contains examples of issues, as well as actions for journal editors to take.
According to the International Journal of Cancer, a Wiley published journal, the most frequently found errors are duplicated panels deriving from copy and paste errors, magnification errors in microscopic images, and inappropriate splicing of gel sections together. The prevalence of duplication errors in life sciences manuscripts can be attributed to a variety of factors. Notably, many authors from different
locations can now contribute to the same study and work on the same manuscript, opening the door for duplication errors through human error and miscommunication.
Accidental image duplications can be missed by researchers, editors and peer reviewers because identifying overlapping sections of complex images is difficult for the untrained human eye. Taking many microscopy images – with or without using different levels of magnification – can lead to small overlaps within the same samples. Technically, it is difficult to completely avoid overlaps, and it’s even harder to detect these issues.
The acknowledgement of purposeful manipulations as part of fraudulent research is also unavoidable. This is an increasingly worrying issue in the academic industry, with most publishers being the target of systemic academic fraud via paper mills. This is the illegal and unethical manufacture and sale of articles, some of which are completely fabricated, by companies to researchers who claim the articles are the fruit of their own research.
Paper mills increase the pressure on the scientific community. When such papers make it through the peer-review process, it undermines the credibility of real research. Publishers and researchers need the tools to help make sure credible researchers are recognised for their contribution to the field.
Paper mill articles are difficult to detect in isolation, but comparisons of multiple papers from different sources makes it much easier. The review process must adapt to cover unusual similarities or the use of stock images across several papers. As already mentioned, the joint efforts of publishers are a start, but a wider collaboration between publishers and investigators is necessary to ensure awareness and effective action across the whole academic sector.
According to a recent report, one publisher found that 77 of its published journals were affected by fraudulent papers, with an average of 14 per cent of articles affected in each journal published or submitted between 2019–2021. Catching fraudulent papers before they reach publication will reduce the risk and associated costs of academics conducting future research built off low integrity papers.
Any published work with image integrity issues can have a lasting negative impact on all involved parties once retracted. For the publisher, retractions can tarnish the journal’s impact factor, as readers may question the journal’s credibility after a retraction. Institutions associated with the study may also experience reductions in trust and funding.
Researchers will also face consequences for image integrity issues, even if it was an honest mistake. If an image issue is
reported post publication, the publisher must take action, leading to a long and costly investigation for the researcher, during which they might struggle to gain funding for other projects or publish other work.
An often-overlooked consequence for researchers is the already prevalent mental health issues faced particularly by PhD students. One study found that more than 40 per cent of PhD students in the UK met the criteria for moderate to severe depression or anxiety. The high pressure and workload that researchers experience contributes to the increased likelihood of mistakes, and the greater mental impact that rejections or retractions can have. These consequences need to be understood by both researchers themselves and their institutions to ensure their safety and quality of work.
The consequences felt by the prevalence of poor scientific integrity encompass everyone involved in academia, and thus needs to be recognised and actioned by all parties as well. Collaboration between researchers, institutions and publishers can ensure innocent parties are corrected, guilty parties are punished and that only the research of most integrity is published.
The technological revolution has had prominent effects on almost every industry, and academia is no exception. Increased access to high quality imaging equipment gives researchers the tools they need to ensure they can convey results using high-quality images. A study found that as many as 72 per cent of cell biology1 related papers included image-based figures to convey results, highlighting the prevalence and importance of images to manuscripts.
The increasing commonality of images in papers has made interpreting results more accessible, as digesting visual
stimuli can be easier than processing text. Despite this, it has not endured the same scrutinisation as text during quality assurance checks, a problem exposed in research from image data integrity analyst Jana Christopher, who found when reviewing manuscripts checked at acceptance, the percentage of manuscripts flagged up for image-related problems ranges from 20 to 35 per cent.2
As the format of research papers evolve, we should also consider how the traditional peer-review process should evolve. This is particularly true for the image integrity review process, which is traditionally checked manually. It can be difficult, or even impossible to compare variations between sub-images by eye, supporting the need for tools to assist. Plagiarism software, such as iThenticate has long been established and widely used to detect plagiarism in education, so why has there been so little development for automated image checking software?
Recent exciting developments in AI and computer vision technology have allowed for more advanced methods of checking images. The trend has therefore been for publishers to adopt software, such as Proofig, as part of their review process.
Anyone in academia can use AI software for quality assurance and to check images for possible duplications or manipulations in minutes, streamlining the review process. Computer vision also works more quickly and accurately than the human eye, reducing the risk of image integrity issues being missed before publication.
The use of such software can also provide an extra level of confidence for researchers, journal editors and grant committees. Researchers can proactively check their papers so that they can be confident that their work has the best chance of being published with no accidental image integrity issues tripping them up. For journal editors, they can be confident in the knowledge that published work is of the highest quality or thoroughly investigate any reports of issues and grant committees can make sure that they provide the grants to the best candidates.
No scientist wants their integrity called into question unjustly, so by using automatic image checking software before submission, researchers can check their data while keeping it confidential. This shifts the focus to the view that researchers are to be helped and encouraged toward high quality science rather than demonised.
The benefits of effective image integrity checking software are evident. By checking images proactively, journals can maintain or improve their impact factor and secure the quality


of future research. Institutions and funding bodies can better recognise valuable routes of research that will have the most significant positive impact for the community and researchers can be confident that they are sharing impactful research with accurate data.
Although retraction rates are high, and scientific integrity is facing challenges, there are actions that can be taken to improve integrity. Tools such as Proofig are vital for the future of the scientific community in ensuring that only the most credible research is published, and the consequences of problematic papers and retractions are minimised.
1. https://journals.plos.org/plosbiology/article?id=10.1371/journal. pbio.3001161
2. Jana Christopher, M.A., Image Integrity Analyst https://ukrio.org/ research-integrity-resources/expert-interviews/jana-christopherimage-integrity-analyst/
Dr. Dror Kolodkin-Gal, Ph.D. is a life sciences researcher that specialises in new ex-vivo explant models to help understand disease progression and treatments. During his research, he became familiar with the issues surrounding image duplication and image errors in scientific publications. Dror co-founded image check software provider Proofig to help colleagues avoid unnecessary reputational damage and the financial implications of an investigation into their careers, as well as academy institutions and publishing houses. Dror and his teams created Proofig’s artificial intelligence algorithms to help detect image duplication and manipulations in scientific papers. The software checks papers prior to submission and publication, preventing unexpected rejections and helping to improve article quality and credibility.





There is growing excitement about the potential shown by cell and gene therapies, particularly in rare diseases. First, though, these therapies face challenges both in development and in aligning to regulatory guidance that was established long before the advent of advanced therapeutic medicinal products (ATMPs). Francesco Lanucara of PharmaLex explores the challenge of navigating guidelines that don’t always reflect the complexity of ATMPs and the importance of achieving regulatory convergence across different regions.
There have been significant advances in the field of cell and gene therapy in recent years with the approval of a growing number of therapies that target rare diseases. As knowledge is continuously gained on key aspects of the manufacturing processes and the quality attributes of cell and gene therapy products, regulatory guidance also continues to evolve.
Both the European Medicines Agency (EMA) and US Food and Drug Administration (FDA) have been busy in the past few years publishing new guidance for advanced therapeutic medicinal products (ATMPs). For example, the FDA produced two new guidances this year – one on CAR T cell products1 and one focused on products incorporating genome editing (GE) of human somatic cells.2
Largely, though, developers have had to find ways to work with long-established ICH guidelines that were designed with more conventional biotechnological products in mind, such as monoclonal antibodies. Due to the complexity of ATMPs, the regulatory framework has evolved differently in various jurisdictions, as is reflected by the diverse approaches from EMA and FDA to aspects of the development process, particularly with regards to implementation of GMP compliance and the definition of starting materials.
The evaluation and regulation of cell and gene therapy products would benefit from greater convergence and harmonisation of requirements and standards across different regions, supported by collaboration between industry, non-profit, academic and other organisations, and regulatory authorities.
The ICH was established more than 30 years ago as a global platform for harmonisation of technical guidelines and requirements for the development and registration of pharmaceutical products. Today ICH has 20 members and 35 observers, and many health authorities worldwide now apply ICH guidelines to their regulatory framework. Some countries take ICH guidelines that don’t easily fit to the complexity of ATMP medicines, resulting in developers of
ATMPs struggling to meet expectations during the evaluation of their submissions.
While ICH has developed some guidelines relevant to gene therapies, for example, guidance on nonclinical biodistribution studies in the development of gene therapies, 3 many activities covered by well-established ICH guidelines don’t easily apply to cell and gene therapies. There is, therefore, a need for guidance to be updated to take into consideration the variety, complexity and challenges of cell and gene therapies.
As an example, requirements for batch release testing cannot be applied in the same way to cell-based products as they are to an antibody. Typically, with cell-based products, tissue is taken from the patient, which is then genetically modified and returned to the patient. Cell-based products are often characterised by short shelf-lives, challenging the execution of traditional release testing, such as sterility, in a time frame that allows delivery of the product to the patient without compromising the product quality.
The challenges associated with ATMPs are recognised by schemes such as EMA’s PRIME programme, which provides developers of innovative ATMPs with options to adapt their CMC (chemistry, manufacturing and controls) development to the restricted timelines that are typically faced in the approval of these products. As an example, alternatives to the standard process qualification and validation as described in the ICH are described for ATMP programmes, where the number of batches manufactured at the time of submission of Marketing Authorisation Application may be limited.
While the flexibility provided by schemes such as PRIME is welcome, harmonised ICH guidance to support ATMPs that can’t go through standard development processes would be preferable since this would ensure a smoother process across all regulatory authorities.
The pathways for ATMP developers are also made more difficult by differences in what regulators in Europe and the US require to assess clinical trial applications (CTAs). Drug developers typically outsource production to contract development and manufacturing companies (CDMOs) who often restrict proprietary information on the manufacturing process to Drug Master Files (DMFs) or Regulatory Support Files (RSFs) which are submitted to the agency for evaluation but are not visible to the sponsor.
The new Clinical Trial Regulation (CTR), which came into effect in the EU on 31 January 2022, does not include the option to submit a separate supporting file (similar to a DMF or RSF) for investigational medicinal products as part of the Investigational Medicinal Product Dossier (IMPD).




by regulators in another region to inform their decisionmaking – could be of particular value for gene therapies, whose complexity could strain the infrastructure of smaller regulatory agencies. “For example, approval of a gene therapy product by the FDA or EMA could form the basis for approval in other countries, leveraging the dossiers used to support initial approval,” the authors wrote.
There are efforts underway to better standardise and harmonise processes and improve industry-regulatory collaboration. For example, the FDA has joined a publicprivate consortium, the Bespoke Gene Therapy Consortium (BGTC) which is part of the Accelerating Medicines Partnership program.8 The goal is to build platforms and standards to speed the development and delivery of gene therapies. More such efforts are needed to achieve the objective of bringing innovative, life-changing gene and cell therapies to patients.
Additionally, Annex VI of the new CTR states specific labelling requirements for IMPs, including labelling of the expiry date on the immediate packaging, which challenges the practicality of updating expiry dates for those packaging configurations designed to store the product in frozen conditions, such as the cryobags typically used for cell-based ATMPs. This requirement is a further issue for sponsors who initiated clinical trials in jurisdictions outside the EU and are now having to redevelop their labelling to comply the Annex VI.
While the introduction of the CTR poses some issues, the new regulation does bring harmonisation to CTA evaluations. Previously, the clinical trial evaluation was country-specific in Europe, which meant companies had to deal with different expectations with their ATMP trial applications. With the CTR, the application will be reviewed by one body, representing many countries, and applicants will receive one EU-based opinion, rather than many national opinions. This is expected to speed up clinical trial approvals.
ATMPs face another hurdle that other regulated products do not: mutual recognition. The EU has mutual recognition agreements with many other authorities for conformity assessment, which, among other things, allows authorities to waive batch testing of products imported into their territories.4 This agreement does not extend to ATMPs, which means sponsors must retest batches in the EU before their cell or gene therapy can be released in the EU by the qualified person (QP).
There have been exceptions with cell and gene therapies where companies were able to justify not retesting based on the limited amount of material, as was the case for Luxturna5 and Zolgensma.6 While the European public assessment reports for both products noted that the mutual recognition agreement for GMP between the US and EU or UK does not apply to ATMPs, GMP guidelines do allow some flexibility for release testing due to the small batch size of these orphan products.

As the authors of a June 2021 paper in Molecular Therapy noted,7 regulatory reliance and work sharing between regions – where regulators in one region use assessments performed
1. https://www.fda.gov/regulatory-information/ search-fda-guidance-documents/considerations-developmentchimeric-antigen-receptor-car-t-cell-products
2. https://www.fda.gov/regulatory-information/ search-fda-guidance-documents/human-gene-therapy-productsincorporating-human-genome-editing
3. ICH guideline S12 on nonclinical biodistribution considerations for gene therapy products, ICH guideline S12 on nonclinical biodistribution considerations for gene therapy products
4. Mutual recognition agreements (MRA), https://www.ema.europa. eu/en/human-regulatory/research-development/compliance/ good-manufacturing-practice/mutual-recognition-agreements-mra
5. Assessment report, Luxturna, September 2018, https://www.ema. europa.eu/en/documents/assessment-report/luxturna-epar-publicassessment-report_en.pdf
6. Assessment report, Zolgensma, March 2020, https://www.ema. europa.eu/en/documents/assessment-report/zolgensma-eparpublic-assessment-report_en.pdf
7. Global regulatory progress in delivering on the promise of gene therapies for unmet medical needs, Molecular Therapy: Methods & Clinical Development, June 2021, https://www.sciencedirect. com/science/article/pii/S2329050121000668#:~:text=Review-
The Accelerating Medicines Partnership Bespoke Gene Therapy

(BGTC), https://ncats.nih.gov/programs/BGTC
Francesco Lanucara is Senior Manager Regulatory Affairs CMC, Biopharma Excellence. Francesco joined Pharmalex (BioPharma Excellence) in June 2021 and has since been providing CMC and regulatory support for ATMP projects, including in vivo and ex vivo gene therapy. Previously, he held a number of roles as analytical lead and analytical development senior scientist in the biopharmaceutical industry. Francesco received his PhD in Pharmaceutical Sciences from the University of Rome in 2008.
Extractable and leachable studies on primary packaging systems are well established in the pharmaceutical industry. For extraction studies, guidelines and best practice guides mandate a worst-case approach, taking the active, the formulation and the container closure system into account. The data from the extraction study should enable a meaningful risk assessment about the possible occurrence of impurities leaching from packaging components during the products shelf-life. The guidelines and best practice guides recognise packaging materials as a potential source of impurities and assess their direct toxic or genotoxic effect on the patient. However, an assessment of the protein-reactivity of extractables are not in the scope of standard extraction procedures. Changes to the protein structure caused by compounds acting as a catalyst or by direct covalent reaction, may render the Biopharmaceutical inefficacious or even immunogenic. Previously, we have described a screening assay for packaging material extracts, to identify possible protein-reactive extractables, enabling an assessment including the risk of possible leachable having a direct or indirect effect on the protein structure. However useful this proposed assay is, it only allows an evaluation of the reactivity of extractables during the extraction process. It does not consider extractables, which are not reactive per se, but may be converted to a protein-reactive derivative caused by aging processes, which might occur over the shelf-life of the product. In this article, we propose a modification of the protein-reactivity screening, by adding an electrochemical oxidation step, to not only evaluate extractables, which are reactive during the extraction process, but to also see, if there is a subset of extractables, which oxidised derivatives have protein reactive properties. This modified assay does not only evaluate the reactivity of extractable during the extraction process, but also takes into account, that leaching processes are time dependent and therefore, potential leachable are like the drug product prone to aging dependent degradation or modification, which may have an impact on the reactivity of the compound.
Biopharmaceuticals, drug products with protein- or peptidebased active ingredients, are mainly administered as parenteral solutions. These solutions prepared either prior to application by reconstitution of a lyophilized product with a suitable diluent or are formulated directly as a liquid-for-injection. Parenteral drug products are mainly stored in glass container closure systems sealed with a rubber stopper/septum; the standard vial-stopper configuration. In some cases, the product may be filled directly into syringe, a so-called pre-filled syringe. These consist of a glass barrel, which may be lubricated, a rubber-based plunger and a syringe needle held in place by an adhesive and a capping device. All these components and adhesives are potential sources of leachables, which may migrate into the product over it´s shelf life. To evaluate the risk of leachables migrating into the product,
extraction studies are performed. Extractions studies should be designed in a way, that they represent a worst-case scenario in terms of the extractive properties of the extraction media and extraction conditions, mainly temperature and time. Here it is important to note, that a forensic-style evaluation the primary packaging, e.g. by completely dissolving each component under the harshest of conditions, does not give rise to a representative extraction profile. The USP chapters <1663> and <1664> offer guidance on the design, justification and evaluation of data from extractable and leachable studies, but do not propose exact experimental conditions for extraction studies.1,2 The Product Quality Research Institute (PQRI), however published a widely accepted best practice guides for Orally Inhaled and Nasal (OINDP) as well as for Parenteral and Ophthalmic Drug Products (PODP).3,4 The guideline covering parenteral formulations, proposes three different extraction media considering aqueous buffered formulations at basic and acidic pH, as well as water with organic solvent to simulate the extractive properties of often highly concentrated protein-based actives and excipients like polysorbates, aiding protein solubility. The guideline also proposes a Safety Concern Threshold (SCT) considering the parenteral and ophthalmic route of administration, under which a daily exposure to an unknown compound is considered to likely have no adverse effect on the patient. The SCT is an extrapolation of no observed effect levels (NOEL) obtained for different substance classes in animal models.5 For the evaluation of the extraction profiles, the SCT is translated into an analytical evaluation threshold (AET), which takes into account the maximum daily delivered dose of the drug and the extraction volume. Any extractable, which falls short of the concentration limit defined in the AET, are not further evaluated, since they are unlikely to either leach in the product over it´s shelf life or at least are very likely to stay under defined SCT. Compounds in the extract, that are detected above the AET need to be identified and toxicologically assessed to evaluate whether the compound needs to the monitored during a leachable study. The analytical techniques applied must be capable of detecting a single compound, in case of a leachable study, or multiple compounds from an extraction study at the defined AET level. Furthermore, for the evaluation of extracts the analytical techniques must be suitable to detect an array of extractables from inorganic compounds, e.g. metals from glass components, to organic compounds with divers physico-chemical properties, e.g. from rubber components or adhesives.
The general concepts of the guidelines mentioned above regard extractables and leachables as compounds, which may have a direct concentration-dependent genotoxic, toxic or other ways adverse effect in the patient. The evaluation based on SCTs reflects the approach described in guidelines concerning genotoxic and toxic impurities e.g., ICH M7.6 For protein-based biopharmaceuticals however, an evaluation of extractables purely on a NOEL concept does not consider the potential direct effect an extractable may have on the active itself. This may be a covalent reaction of an extractable with an amino acid side chain




or by acting as a catalyst by e.g., oxidising amino acids prone to oxidation, as already shown for some metal ion leachables.7
Apart from this being a potential quality issue, the slights changes to the amino acid sequence can render a protein inefficacious, altering the three-dimensional structure, causing e.g. aggregation,8 or in a worst-case scenario, triggering an immune response in patients. An immune response can lead to the induction of anti-drug antibodies (ADA) changing the drugs pharmacokinetic properties9 or, in case the ADA binds to the active site of the drug (so-called neutralising antibody), rendering the drug completely inefficacious in a patient, often for life.10 Because immunogenic reactions and their severity are highly dependent on the immunogen, the route of administration and the individual genetic makeup of each individual patient, there are no established SCT levels for potentially immunogenic substances available. Le et. al. however, have proposed a limit for protein modifications based on LC-UV peptide mapping data. They suggest that modifications greater than 2% on peptide level should be investigated in regard to immunogenic effects.11 Furthermore, biopharmaceuticals such as monoclonal antibodies, have a large molecular weight, making it difficult to observe small mass modifications using established standard stability indicating methods. Even the use of sophisticated mass spectrometry applications has its limitations, if screening low level unknown or unexpected modifications. Therefore, a screening assay for protein-reactive extractables is as useful tool to enable a comprehensive risk assessment, based not only on the abundance of each individual compound in the extract in relation to the defined AET, but also indicates which of those compounds might be protein-reactive. The additional information about protein-reactive compounds enables the analyst to either conduct further experiments to verify, if the extractable also reacts with the biopharmaceutical or to aid a screen for such modifications in stored drug product samples.
We have previously described a screening assay for proteinreactive extractables, which can be directly integrated into the extraction process. The screening-assay we proposed uses Glutathione as a surrogate compound. This surrogate is a worst-case scenario when it comes to mimicking the reactivity of amino acids, because in addition to a primary amino group, it also offers a highly reactive free thiol. Other screening assays using peptides or small proteins with no or closed disulfide-bonds as surrogate compounds, arguing that these more closely resemble the drug product. We however believe that Glutathione, as a more reactive compound, is in line with the worst-case evaluations proposed in the guidelines discussed above. Already our assay has proven useful to indicate protein-reactivity of several rubberoligomers readily found in butyl-rubber extraction studies.12 But more importantly, the assay helped to identify polysulfides, which are formed by vulcanising agents during the vulcanising process of rubber materials as potential agents capable of modifying disulfide bonds in proteins. These polysulfides usually go undetected in extraction studies, mainly because polymeric substances of undefined chain-length are challenging to analyse, especially so, if they are inorganic. Even though the screening assay we have proposed has shown its use to indicate protein-reactive extractables, it only identifies compounds which are reactive during the extraction experiment. Since leaching processes are time dependent, the extraction studies are performed under accelerated conditions, namely elevated
temperature. We recommend 121°C for eight hours. As conditions like this accelerate the extraction process, mimicking the leaching of compounds from the immediate packaging system over the products shelf-life, it does not accelerate aging processes, apart form those which are solely temperature dependent. Therefore, compounds that leach into the product over time are, like the drug substance, prone to aging-dependent degradation, e.g. by oxidation. Therefore, we propose an addition of the established protein-reactivity screening by oxidising extracts to evaluate, if any of extractables designated as non-protein-reactive can be converted into protein-reactive degradation products. For the oxidation, a method described by the work group of Uwe Kaarst,13 which utilises electrochemical oxidation to simulate cytochromemediated activation of drug substances, was adapted. As a proof-of-concept and to establish the oxidation procedure, two commonly found rubber extractables, Dibutyl hydroxytoluene (BHT) and Dimethylethyl hydroxyphenyl (DTHP), a degradation product of IrganoxTM, were used.14,15 These Hydroxytoluene’s are commonly used as antioxidants in rubber formulations and were not indicated as protein-reactive in our Glutathione screening assay. However, these compounds can be converted into Quinone methide (QM) derivatives upon oxidation, which are nucleophilic and therefore should be potentially protein reactive. The addition of an oxidation step to the Glutathione screening assay proposed here, should increase our understanding of the potential fate of compounds leached from the immediate packaging system into the to drug product over it´s shelf-life. The additional information gained from these experiments will enable a more comprehensive risk assessment of the extraction study.
L-Glutathione reduced (Cat.No.: G425); human Angiotensin II (Cat.No.: A9525) and Dibutyl hydroxytoluene (BHT) (Cat.No.: W218405) were purchased from Sigma Aldrich/ Merck KGaA Darmstadt, Germany. Isopropanol (Cat.No.: Nr. AE73.2), Acetone (Cat.No.: KK40.1) and Acetonitrile (Cat.No.: HN40.2) were purchased from Carl Roth GmbH & Co. KG Karlsruhe, Germany. Ammoniumacetate (Cat.No.: 012441) and Formic Acid (Cat.No.: 069141) were purchased from Biosolve B.V. Valkenswaard, Netherlands. Dimethylethyl hydroxyphenyl (DTHP) was purchased from ABCR GmbH, Karlsruhe, Germany.
The electrochemical oxidation was performed with 500 µL of diluted solutions of BHT and DTHP in a ESA Coulochem II installed with a cell 5021 at a flowrate of 50 µL per minute at 700 mV. For the control samples, the voltage in the coulometric cell was set to 0mV. BHT and DTHP were each diluted to a concentration of 0.5 mM in 50% acetonitrile in water prior to treatment in the coulometric cell. The oxidised BHT and DTHP were each incubated with and equal volume 0.1 mM solution Glutathione at 37°C for 30 min (5:1 ratio of BHT/DTHP to GSH). Angiotensin II diluted to 0.2 mM and treated with and equal volume of BHT and DTHP (1:2.5 ration of Angiotensin to BHT/DTHP).
For the rubber stopper extraction, 1.5 g of a bromo butyl stopper was cut in small pieces and extracted for 8 h at reflux in 5 ml 2-PrOH. The extract was then diluted 1:1 with with 20 mM ammonium acetate in water. 500 µL of the diluted extract was subjected to the coulometric cell and incubated with Glutathione as already described.
The samples were separated on a Shimadzu Prominence LC20 HPLC System equipped with an Inertsil C8, 100x2.1 mm, 5 um column heated to 50°C. For analysis, 10 µL of samples were in injected into a 300 µL per minute flow. The separation of the samples performed with the following mobiles phased: Eluent A: 0.1% Formic Acid in water and Eluent B: 0.1% Formic Acid in Acetonitrile. The Glutathione treated samples were separated by an HPLC gradient starting at 50% eluent B, which increases to 100% B within 3 minutes and remains at 100% for additional 4 minutes before returning to the starting condition. The Angiotensin II treated samples were separated by an HPLC gradient starting at 10% eluent B which increases to 100% B within 5 minutes and returning to the starting condition after 0.1 minute.
The HPLC flow was directed into an Orbitrap XL system equipped with and ESI ion source. The ion source parameters were set to positive ion mode with a spray voltage of +5kV, tube lens at +90V. The resolution of the mass detector was set to 30000 and the mass range was set to 100 to 1000 amu for the GSH samples treated with BHT and DTHP, 300 to 1500 amu for the Angiotensin samples treated with BHT and DTHP and from 100 to 1500 amu for the GSH samples treated with the rubber extract.
The optimal voltage for the electrochemical conversion of Hydroxytoluene based antioxidants in coulometric cells has been previously described by McCabe and Acworth to be between 675 mV and 825 mV. The conversion rate has been reported to be at about 100%.16 Therefore, we have decided to set to coulometric cell to 700 mV. For the establishment and proof of principle we used standards of antioxidants typically found in rubber formulations as well as in PE and PP-plastic. Whereas PE- and PP-primary packaging materials are commonly not used to store therapeutic protein, butyl-rubber materials are typically used as vial-stoppers or syringe-plungers of many marketed Biopharmaceuticals. Both antioxidants are commonly detected in extraction studies.14,15 The Hydroxytoluenes Dibutyl hydroxytoluene (BHT) and Dimethylethyl hydroxyphenyl (DTHP), a degradation product of IrganoxTM, convert in the coulometric cell to their quinone methide derivatives, which represent reactive (electrophilic) intermediates (Figure 1).
In the screening assay described here, Glutathione is used as a surrogate for amino acid side chains in biopharmaceuticals. The Glutathione (GSH) added to the electrochemically
activated antioxidants should represent potent reaction partners for the quinone-methides (QM), resulting in the respective Glutathione-BHT-QM or -DTHP-QM conjugates (Figure 2).

Figure 2: Reaction scheme of Glutathione (GSH) with the oxidised Dibutyl hydroxytoluene quinone method (BHT-QM).

Electrochemically activated BHT and DTHP samples were treated with Glutathione and subsequently analysed by LC-MS. The LC-MS method applied was the same as in the previously described screening assay.12 The reactivity-assay with Glutathione was performed with BHT and DTHP, which were either subjected to electrochemical activation in a coulometric cell or left untreated. The treated and untreated samples were subsequently analysed by LC-MS and screened for masses corresponding to the Glutathione-quinone-methide conjugates. The Glutathione-BHT-QM conjugate should have a mass of 526.26 amu and the Glutathione-DTHP-QM conjugate of 584.26 respectively.
The experiments highlighted in Figure 3 clearly support the hypothesis, that the unreactive antioxidants BHT and DTHP can be converted into their reactive quinone-methide derivatives, which readily react with the Glutathione surrogate compound offered as a reaction partner.
Reaction of Electrochemically Activated Antioxidants with Angiotensin II
Glutathione with its free thiol is a very reactive compound, therefore it is often argued, that it is not a suitable surrogate to evaluate the protein-reactivity of extractables. It is true, that biopharmaceuticals usually do not contain amino acids with free thiols and that all cysteines in the sequence are paired with another cysteine to form a less reactive disulfide-bond. To
Figure 1: Scheme of the electrochemical conversion of Dibutyl hydroxytoluene (BHT) and Dimethylethyl hydroxyphenyl (DTHP) at 700 mV in a coulometric cell to their respective quinone-methide (QM) derivatives. Below the molecules their masses are given in atomic mass units (amu).
Figure 3: Results from the LC-MS based screening for Glutathione-quinone-methides conjugates. The peaks in Total Ion Chromatrogams (TIC) represent the main component in each experiment. In the experiments with the untreated Hydroxytoluenes Dibutyl hydroxytoluene (BHT) and Dimethylethyl hydroxyphenyl (DTHP), Figures A and C, on ions representing the Glutathione-quinone-methide conjugates could be found in the mass spectra. Whereas in the samples with the electrochemically activated BHT and DTHP, Figures B and C, the corresponding signals, indicating the presents of GlutathioneBHT-QM (526.26 amu) and Glutathione-DTHP-QM (584.26 amu) could be identified in the mass spectra. Further more the Extracted Ion Chromatograms (XIC) of the proposed conjugate masses, indicate real compound eluting from the column.
evaluate, if the quinone-methides generated by electrochemical activation in a coulometric cell, also react with other amino acid side chains, we performed the same experiments using Angiotensin II as a reaction partner. Angiotensin II does not contain any disulfide-bond or cysteines for that matter. Like in the experiments before, BHT and DTHP were with treated in the
coulometric cells or left untreated and then added to the reaction partner. In the following only the results for the results from the experiments with BHT as shown as an example. The experiments carried out with DTHP led to the same results (data not shown).
The experiments clearly indicate, that BHT converted to its reactive quinone methide intermediate by electrochemical activation, reacts with Angiotensin II giving rise to its conjugate (Figure 4 B and E). This conjugate can be fragmented by in-source fragmentation to liberate the BHT-QM, further proof of the conjugate (Figure 4 F). As expected, the untreated BHT did not react with Angiotensin II.
The experiments with Angiotensin II firstly underline, that the quinone-methide derivatives of Hydroxytoluene-based antioxidants are very likely protein-reactive. Secondly, that at least for this class of substances, the screening assay using Glutathione as surrogate compound is predictive for studying the potential protein-reactivity of extractables subjected to simulated oxidative aging.
Electrochemical Activation of a Butyl-rubber Stopper
For proof of principle, a rubber stopper extract was used, because this packaging material is more relevant for Biopharmaceuticals. In the following example a bromated butyl-rubber was extracted by a sealed-vessel extraction procedure with Isopropanol as an extraction medium. The extract was subjected to a coulometric cell and electrochemical oxidation was achieved by applying a voltage of 700mV. As a control, an aliquot of the same extract was placed in the coulometric cell without applying a voltage. Both extracts were subsequently incubated with the Glutathione surrogate compound. The previously described LC-MS method was used to screen for Glutathione conjugates indicative of reactive extractables (see Figure 5).
As previously described the rubber extract contains BHT as a typical extractable. This extractable does not react with the Glutathione surrogate molecule, as we could show previously
Figure 4: Mass spectrometric analysis of Angiotensin II samples treated with BHT and BHT converted to its quinone-methide derivative. In the sample where Angiotensin was incubated with BHT (Figures A) no signals corresponding to conjugates (1263.72 amu) could be identified. On the other hand, where BHT was converted to its quinone-methide, an extracted ion chromatogram indicative of the Angiotensin II BHT-QM conjugate could be identified at 4.5 minutes (Figures B)). The corresponding mass spectrum features the signal of Angiotensin II at 1045.56 amu und another signal shifted by 218.17 amu, indicative of the conjugate (Figure F). Furthermore, if an in-source fragmentation is performed, the BHT-QM can be liberated from the conjugate, resulting in a signal at 219.18 amu which leads to an extracted ion chromatogram with the same retention time as conjugate (Figure D)).



to know more?





Figure 5: Extracted ion chromatograms (XIC) of 526.26 amu the mass representative for the Glutathione-BHT quinone methide (GSH-BHT-QM) conjugate. The upper XIC displays the trace obtained form the extract subjected to 700mV. The lower trace represents the control sample where no voltage was applied.

with our screening assay for electrophilic extractables.12 Only if the rubber extract is subjected electrochemical oxidation by means of applying a voltage in a coulometric cell, a Glutathione conjugate with BHT-QM can be observed (see Figure 5). This clearly shows that the approach of electrochemical oxidation can be successfully applied to real packaging material extracts to simulate aging-dependent oxidation of extractables.
The previously described screening assays to evaluate the protein-reactivity of compounds in packaging material extracts12 have been shown to give useful additional information to conventional extraction studies. The information from theses reactivity screenings enables a more comprehensive risk assessment of the extraction study. Whereas a conventional extraction study only allows to evaluate the risk of individual compounds based on their abundance in respect to a predefined AET, a reactivity screening, highlights compounds, which are difficult to monitor, once reacted with the biopharmaceutical drug substance. Knowledge about these compounds enables the investigator to perform further experiments, e.g. to screen for packaging alternatives which yield less protein reactive extractables, to evaluate the real risk of a drug substance to be influenced by a protein-reactive compound, to employ additional methods the monitor potential reaction products in stability- or leachable studies, or to come to the conclusion, that there are no further actions required. Whatever the outcome of a risk assessment based on a reactivity screening might be, it is needless to say, that a potential risk can only be evaluated, if it is known.
Based on the idea to broaden the foundation of the risk-based evaluation of extraction studies, we propose to include an evaluation of aging-associated reactions of extractables. The reactivity screening assays already proposed,
only evaluate the reactivity of extractables during the relatively short extraction process, usual several hours or up to a day.11,17 Therefore, extraction studies can be viewed as an accelerated leachable study, however they are definitely not set up as accelerated stability studies of the leached compounds. This excludes an evaluation of the fate of potential leachabes during the shelf-life of the product. There is a possibility, that some of the commonly found non-reactive extractables might degrade over time to form protein-reactive compounds. Therefore, a risk assessment based on an extraction study with reactivity screening will fall short to evaluate potential aging-associated degradation of leachables over the self-life of the product.
One of the common aging-related reactions monitored during stability studies are oxidations, which affect not only the drug substance and excipients, but all substances in the drug product, including leachabes. We have established an electrochemical oxidation using a coulometric cell. This approach has been previously successfully applied to study CPY-mediated oxidative conversion of small molecule drug substances.13,18 To establish the oxidative aging of packaging material extracts, two commonly found rubber extractables were used. Dibutyl hydroxytoluene (BHT) and Dimethylethyl hydroxyphenyl (DTHP), a degradation product of IrganoxTM, are typical antioxidants used in rubber formulations.19,20 These Hydroxytoluene based antioxidants, which are not protein reactive are known to be converted into electrophilic quinone-methide intermediates (Figure 1).21 In this study these two antioxidants have been subjected to electrochemical oxidation, to evaluate if this approach can be applied to simulate aging-dependent oxidation. The experiments shown here clearly indicate that BHT and DTHP can be oxidized to their respective quinone-methide derivatives, which expectedly react, like all previous tested electrophilic extractables, with the Glutathione surrogate compound (Figure 3). To address the argument, that Glutathione is a too reactive surrogate to study protein-reactivity, the same experiments were repeated with Angiotensin II as a surrogate. Angiotensin II is a polypeptide with eight amino acids, none of which have a reactive free thiol and therefore features amino acid side chains that are more representative of common therapeutics proteins. The results of these experiments confirm, that BHT (Figure 4) and DTHP (data not shown) can be oxidized to yield electrophilic quinone-methide derivatives, which are capable of reacting with less-reactive amino acid side chains. Which of these amino acids are involved in the reaction with the quinone-methides still needs to be investigated.
A proof of principle experiment with an extract obtained from a bromated butyl rubber stopper, commonly used to seal glass vials containing Biopharmaceuticals, could show that the procedure of electrochemical oxidation can be applied to real packaging material extracts. The BHT extractable, as expected, does not react with Glutathione as could be shown previously.12 However, if the extract is subjected to electrochemical oxidation, BHT is converted to its reactive quinone methide derivative which readily reacts with Glutathione (Figure 5).
The reactivity screening of packaging material extracts after electrochemical oxidation, is a valuable addition to the previously described reactivity assay. Whereas, the commonly used assays are successful in highlighting electrophilic
extractables as protein reactive, they do not account for the potential fate of leachables over the shelf-life of the drug product. During storage, aging-processes, e.g. oxidation may convert previously unreactive leachables into proteinreactive degradation products as could be shown here for the Hydroxytoluene-based antioxidants. The finding, that Hydroxytoluenes can be converted into electrophilic quinonemethides by oxidation is not particular surprising. However, the routine application of this approach to extraction studies of different packaging materials, might enable the identification of a previously overlooked extractable, as it was the case for polysulfides and their possible interaction with disulfide discovered previously.12
Do any of the already identified protein reactive extractables or possible reactive degradation products of leachables pose any real danger to patient safety in terms of eliciting an immunogenic response by modified biopharmaceuticals? At least the great majority of biopharmaceuticals marketed to date in standard immediate packaging systems suggest there is not. But for the sake of a thorough risk assessment, it worthwhile to make the effort, because we are only able to assess risks that are aware of!
1. USP <1663> Assessment of extractables associated with pharmaceutical packaging/delivery systems
2. USP <1664> Assessment of drug product leachables associated with pharmaceutical packaging/delivery systems
3. Paskiet, D.; Jenke, D.; Ball, D. et al. The Product Quality Research Institute (PQRI) Leachables and Extractables Working Group Initiatives for Parenteral and Ophthalmic Drug Product (PODP). PDA J Pharm Sci and Tech. 2013; 67: 430-447.
4. Norwood, Daniel L., et al. "Best practices for extractables and leachables in orally inhaled and nasal drug products: an overview of the PQRI recommendations." Pharmaceutical research 25.4 (2008): 727-739.
5. Kroes, Robert, et al. "Structure-based thresholds of toxicological concern (TTC): guidance for application to substances present at low levels in the diet." Food and chemical toxicology 42.1 (2004): 65-83.
6. International Conference on Harmonisation (ICH) M7; Assesment and Control of DNA (Mutagenic) Reactive Impurities in Pharmaceuticals to Limit potential carcinogenic risk.
7. Zang, Li, et al. "Residual metals cause variability in methionine oxidation measurements in protein pharmaceuticals using LC-UV/MS peptide mapping." Journal of Chromatography B 895 (2012): 71-76.
8. Dean, Roger T., et al. "Biochemistry and pathology of radical-mediated protein oxidation." Biochemical Journal 324.1 (1997): 1-18.
9. Hermeling, Suzanne, et al. "Structure-immunogenicity relationships of therapeutic proteins." Pharmaceutical research 21.6 (2004): 897-903.
10. Sharma, B., Immunogenicity of therapeutic proteins. Part 2: Impact of container closures Biotechnology Advances 25 (2007) 318–324
11. Li, Kim, et al. "Creating a holistic extractables and leachables (E&L) program for biotechnology products." PDA Journal of Pharmaceutical Science and Technology 69.5 (2015): 590-619.
12. Haep, Ramona. et al. “Protein-Reactive Extractables - A Screening Assay Which Adds Additional Value to the Traditional E/L Workflow” Pharmind, 1, (2018):104-110.
13. Lohmann, Wiebke, Heiko Hayen, and Uwe Karst. "Covalent protein modification by reactive drug metabolites using online electrochemistry/liquid chromatography/mass spectrometry." Analytical chemistry 80.24 (2008): 9714-9719.
14. Yu, Xiaochun, et al. "A study of leachables for biopharmaceutical formulations stored in rubber-stoppered glass vials." (2010).
15. Sogding, Thorsten, et al. "How sterilization of primary packaging influences the results of E&L studies: as the demands that are being placed on the quality and stability of medications continue to increase, the interactions that take place between the primary
packaging container and filled drug product are becoming increasingly important." Contract Pharma 17.5 (2015): 88-95.
16. McCabe, D. R., and I. N. Acworth. "Determination of synthetic phenolic antioxidants in food using gradient HPLC with electrochemical array detection." American laboratory (Fairfield) 30.13 (1998): 18B-18D.
17. Qi, Li, et al. "A holistic approach of extractables and leachables assessment of rubber stoppered glass vial systems for biotechnology products." Journal of Pharmaceutical Sciences 110.11 (2021): 3580-3593
18. Lohmann, Wiebke, and Uwe Karst. "Simulation of the detoxification of paracetamol using on-line electrochemistry/liquid chromatography/ mass spectrometry." Analytical and bioanalytical chemistry 386.6 (2006): 1701-1708.
19. Lu, Na, et al. "Effectiveness of different kinds of antioxidants in resin-cured bromobutyl rubber vulcanizates." Advances in Polymer Technology 37.6 (2018): 2075-2084.
20. Yehye, Wageeh A., et al. "Understanding the chemistry behind the antioxidant activities of butylated hydroxytoluene (BHT): A review." European journal of medicinal chemistry 101 (2015): 295-312.

21. Minard, Aisling, et al. "The unexplored potential of quinone methides in chemical biology." Bioorganic & Medicinal Chemistry 27.12 (2019): 2298-2305.
ASAS Analytische Standards Andre Stratmann Service Labor GmbH
A&M STABTEST Labor für Analytik und Stabilitätsprüfung GmbH
A&M STABTEST Labor für Analytik und Stabilitätsprüfung
A&M STABTEST Labor für Analytik und Stabilitätsprüfung
Antibody-drug conjugates (ADCs) are a family of targeted therapeutic agents for the treatment of cancer. Compared to traditional small-molecule approaches, ADCs offer enhanced targeting of cancer cells along with reduced toxic side effects, making them an attractive prospect for the field of oncology. An antibody-drug conjugate (ADC) is typically composed of a monoclonal antibody (mAbs) covalently attached to a cytotoxic drug via a chemical linker. As all these components affect the ADC performance in equal measure, their optimisation is essential for the development of successful conjugates.
It has taken a while for this field to take off, but to date, over 100 ADCs are under clinical development. Since December 2021, after several decades of efforts to optimise their key components, a total of 14 ADC drugs have received the marketing approval in different countries worldwide. Coincidently, half of the approved ADCs are mainly used against haematological malignancies, the rest being prescribed by and large for solid tumours.
Medicilon is an integrated contract research organisation (CRO) providing comprehensive one-step new drug R&D for pharmaceutical companies and scientific research institutions around the world. Since May 2022, Medicilon has successfully assisted no less than ten ADC drugs on their path to approval for clinical use, and it’s committed to continuously improving the research capabilities of ADC drugs. As a matter of fact, half of these drugs target the protein HER2 (human epidermal growth factor receptor 2), member of the HER family of membrane tyrosine kinases, developed for many years as an important target in breast cancer treatment.

The design idea of the ADC drugs is to couple antibodies with cytotoxic drugs, to simultaneously exert the high specificity of antibodies and the high toxicity of cytotoxic small molecules. The emergence of ADC drugs fills the gap between antibody drugs and traditional chemotherapeutic drugs, increasing the specificity of drugs and improving the therapeutic window.
When designing an ideal ADC, it’s essential to understand the mechanism of action, for the purpose of identifying the desired features of each of its three components: monoclonal antibody, linker, and cytotoxic small molecule drug (small molecule drugs are linked to monoclonal antibodies through coupling chains).
An ideal ADC is one that retains the selectivity and killing capacity of a mAb while still being able to release the cytotoxic drug in quantities large enough to kill tumour cells. However, each of the steps involved in the mechanism of action is associated with unique challenges that complicate the design of ADCs. The mAb binds to cell-surface antigens expressed
on target cells, is internalised via endocytosis, and then transported to the lysosome, where proteases degrade the ADC. Subsequently, the payload is released and diffuses into the cytoplasm, resulting in cell death.
Compared with traditional tumour treatment methods (radiotherapy and chemotherapy), ADC drugs have fewer side effects and stronger effects on tumour cells. Limited by the high specificity of the ADC drug antigen and the comprehensive factors that satisfy the effect of the ADC drug, the target must not only exist on the surface of tumour cells, but also ensure that it can trigger endocytosis after binding to the antibody to facilitate the transport of cytotoxins into tumour cells. Therefore, the selection of targets is challenging and extremely important.
With more than 18 years of experience in new drug R&D, Medicilon specialises in the development and validation of analysis methods for different targets and can effectively analyse the expression level and accessibility of targets according to specific needs, providing constructive suggestions for target selection.

Essential to the efficacy of ADCs, the selection of highly specific antibodies can greatly reduce the off-target effects of ADC drugs, avoiding the binding of antibodies to the free antigens in the circulation, leading to systemic toxicity, and as a result improving the efficacy and safety of drugs.
When screening for ADC drug antibodies, there is a phenomenon that must be addressed, the so-called “bystander effect”. The bystander effect refers to the fact that some ADCs also exert an antitumor activity on other tumour cells surrounding the target antigen tumour cells, regardless of the target antigen expression status of these cells. The bystander killing occurs either because of the release of cytotoxins before the ADC internalisation or the extracellular diffusion of cytotoxins through the cell membrane. In both cases, the drug is then taken up by and kills surrounding or bystander cells, which themselves may or may not express the ADC target antigen.
In fact, the bystander effect acts like a double-edged sword in the ADC drug development: whilst is beneficial to the ADC efficacy against tumours with heterogeneous expression of target antigens (such as Her2), it may also cause non-tumour tissue death due to toxicity.
Only to contend with the bystander effect, in Medicilon” weaponry” there are more than 200 cancer cell lines which can be selected for the cells with positive and negative expression of ADC target. And the company has a strong capability for cell labelling and further FACS-based cell viability analysis.
With the continuous development of ADC drugs, in an effort to reduce the rejection of foreign proteins such as ADC antibodies by the human immune system, humanised antibodies are widely used, but this does not mean that the development of ADC drugs can skip the determination of immunogenicity.
The immunogenicity test represents an important measurement index for biological drugs, and it needs to be controlled at all stages of the research.

The immunogenicity of biopharmaceuticals may lead to rapid clearance of ADCs in vivo, affecting their PK profiles and related assays. Immunogenicity can also affect the efficacy and safety of ADC drugs and it’s considered a major hurdle to overcome in the development of ADC drugs.
All current ADC antibodies are IgG molecules due to their high affinity for the target antigen and long half-life in the blood. Compared with other IgG molecules, IgG1 has proved to have better binding activity and easier production, representing the first choice in the ADC drug development at the moment.
The screening of antibodies needs to consider the following factors: specific binding, the endocytosis efficiency of the ADC drug mediated by the antigen-antibody complex, and the accurate localisation in cells after endocytosis (such as lysosomes). In addition, the modification of antibodies, such as glycosylation, modification of antibody constant regions or modification of attachment sites, can help to improve the properties and efficacy of drugs.
The four major platforms of Medicilon immunogenicity research provide a variety of technical solutions for antibody immunogenicity testing, to meet the different needs of the customers first and foremost, but also as a means to ensure the accuracy and effectiveness of ADC drug antibody screening results.
The linker, the part of the ADC drug that connects the antibody and the cytotoxin, may seem insignificant, but it’s
another key factor in determining the safety and clinical efficacy of the ADC drug.
When the ADC drug enters the human body, the failed linker will be cleaved and decomposed in the blood, resulting in the early release of cytotoxins before entering the tumour cells and resulting in serious systemic toxic side effects. Therefore, the stability of the linker is critical.
The types of linkers are divided into cleavable linkers and non-cleavable linkers, and each of them comes with advantages and disadvantages. In this regard, the Medicilon team is combining the action sites and indications of the ADC drugs developed, giving reasonable and effective suggestions based on the existing linker system, and verifying the effectiveness with experimental results.
The amount and type of cytotoxins carried by antibodies will also have a huge impact on the effect of ADC drugs, but Medicilon can effectively solve the issue of cytotoxin selection.
In the molecular library of ADC payloads, Medicilon’s drug discovery team has accumulated a variety of different mechanisms of action and different types of cytotoxins for customers to choose from. At the same time, one or several ADC cytotoxins can be customised and synthesized, on demand.
Medicilon's ADC preclinical solution can help customers sail through all the research and development challenges and complexities, and at the same time providing preclinical research and application services that comply with GLP specifications, thus completing the preclinical research and application of antibodies and ADC drugs all in one-stop.
In vivo efficacy test in animals is an important pharmacological parameter in ADC research, which directly reflects the efficacy of ADC and affects the clinical trial design.
Medicilon is committed to providing customers with mature tumour models for evaluating ADC in vivo efficacy, completing the modelling, and feeding of various model animals in an AAALAC-certified environment, and completing relevant pharmacodynamic evaluations with high GLP-like standards test. To date, Medicilon has established nearly 300 tumour evaluation models in six categories, which can cover most conventional tumour diseases.
Due to the complex composition of ADC drugs, their PK properties must be evaluated with multiple analytes, hence increasing the difficulty of analysis.
Medicilon provides a variety of high-quality test methods for various ADC component analytes in the in vivo analysis of ADC drugs, delivering reliable and high-quality PK data by analysing plasma/serum samples collected in animals. Thanks to advanced experimental equipment and high-quality and stable analytical methods, Medicilon can not only benchmark against international experimental standards and obtain results
that are highly consistent with the conclusions of American laboratories, but also ultimately obtain test results that are well correlated with ADC and total antibodies.
The toxicokinetics of ADC drugs is directly related to cytotoxicity. The known side effects of ADC drugs include peripheral neuropathy, skin and ocular toxicity, and symptoms such as hyperglycaemia. To minimise the toxicity risk of ADC drugs, toxicity testing and safety evaluation are particularly important.
Medicilon follows ICH guidelines S6 and S9, customises a personalised safety evaluation plan based on the specific circumstances of each project, and provides safety evaluation services that comply with international GLP standards such as NMPA, FDA, OECD, TGA, including single and repeated dose toxicity test (accompanied by a toxicokinetic study), safety, pharmacology (including tissue cross-reaction) and immunogenicity testing.
Medicilon has in-depth exchanges with customers in the formulation of the preclinical integrated research plan of ADC. The backbone of scientific research, it combines the characteristics of each case with years of practical experience and technical accumulation, carefully submitting high-quality experimental plans and results to customers.


To date, ADC drugs have undergone three generations of technological changes. The application of the third-generation fixed-point coupling technology has made ADC drugs more uniform, stable, and effective, and increasingly better results in treatment have been achieved.
That’s why, currently, an efficient ADC drug needs to comprehensively consider antibodies (target and antibody screening optimisation), small molecule drugs, linkers and linking technologies, along with their most effective combinations.
Medicilon UK office is based in Cambridge, which is close to serve UK and European clients.
Nadine is responsible for Medicilon UK and European market business alliance with research and business partners, develop the business in the region, serve and care the UK and Europe clients. Nadine Su has 15 years’ experience of business development, project management in pharmaceutical and healthcare industries. She successfully led and manage the novel drug research project and form the international partnership to achieve over $20M the licensing deal. She has rich experience to manage and develop the novel technology drug discovery programs from early research till clinical stage with different stakeholders and international scientific team. Her leadership and contribution to make the company had achieved twice of the “the final list of the business award” of Cambridge Business Award competition. Nadine have educated in China and UK for master degree in international Business.






The pandemic laid bare inefficiencies and vulnerabilities across laboratory operations where global supply chain issues, alongside high testing volumes, and the demand for faster turn-around-times disrupted the pace of innovation and productivity.1
Today, rising competition for talent and specialist skills continue to pose a significant challenge to many organisations seeking to expand, whether through traditional recruitment, or through working with contract research organisations (CRO). Recent industry surveys reveal that 80% of pharmaceutical manufacturing facilities are experiencing a skills mismatch,2 and 50% of biopharmaceutical executives find recruiting technically experienced staff challenging.3
New models to support not only operational agility, but also business continuity is required for laboratories across the biopharmaceutical industry to future-proof operations.
The Evolution of Collaboration in Laboratory Operations
Collaboration through R&D outsourcing emerged in the 1980s to support activities such as internal discovery programs, chemical synthesis, and toxicology testing, before its scope widened in the next decade as collaboration flourished. Across 1990, increases in minority, holdings and R&D partnerships drove a greater demand for outsourcing support from CROs, expanding their range of capabilities from activities like screening and combinatorial chemistry to gene expression and bioinformatics.4
While the use of CROs is expected to continue to grow over the next decade, it’s questionable as to whether this trend is out of the efficacy the collaboration offers, or the familiarity the biopharmaceutical, and wider clinical industries have with the method. Despite advantages including improved flexibility, variable costs, and easier exits from unsuccessful programmes, disadvantages in traditional outsourcing models can be problematic.5
Challenges associated with CROs include:
• Measuring causal association and new hypotheses in knowledge-intensive clinical projects
• Potential of regulatory compliance failures
• Potential of know-how leakages
• Inhibited continuous improvement
• Loss of control and oversight at an external facility
Empirical research on the ROI behind using outsourced services is mixed, however, it’s notable that some studies indicating improved R&D performance with outsourced support, utilise data from 2001 and previous.6
Meanwhile, more recent empirical research has shown that biotech firms have a lower innovative performance when using outsourced services, compared to organisations with established internal teams.7
Alternatives to outsourcing continue to emerge as demand for more holistic and unified options for workforces grow across the wider pharmaceutical industry. Out of this, scientific services are growing in popularity, where teams of scientific workers work alongside existing staff at the client’s site, all while being developed and managed externally by the scientific services provider.
These onsite scientific service models enable organisations to free-up and optimise FTE expenditure by embedding highly skilled permanent staff across the permanent workforce. Unlike CROs where external facility complications can add to timelines, an on-site model means sharing onsite project deadline risk, while still benefiting from external scientific expertise onsite to scale according to demand.
The laboratory workforce is fundamental to the operation, and success of any project, making their development and retention critical to business continuity.
In biopharmaceutical organisational that utilise additional support from CROs, minimising temporary labour turnover can be a challenge. What’s more, the pre-existing turnover from temporary labour sources, such as CROs, can drive wider turnover trends. Comprehensive data-analysis on pharmaceutical projects between 1990 and 2017 found that collaborative relationships drove greater attrition rates, compared to instances where the organisation integrated the two teams.8
Carol Jennings, Synergy Operations Director explains, “Business continuity is fundamental to laboratory research, and attrition is a major challenge in the sector. If you’re spending 2 years training an individual for them to leave, you lose a major asset. What’s more, you hinder the momentum of the research. However, if you reflect on your team, and their challenges, and tailor actionable solutions, you can overcome attrition and improve continuity. In science, where things are ever evolving, it’s about having a flexible and agile approach to staff retention in the laboratory.”
In biopharmaceutical research, new models of scientific services address temporary turnover challenges by deploying skilled laboratory teams that they employ directly, are committed to their specialisms, and who can be transferred on to other projects without worrying about job-insecurity in the same way as other temporary contract workers.
This results in a more motivated, dynamic team, where workers supplement each other’s strengths and work together in a unified way on-site.
Laboratory test results play a pivotal role in the world of



healthcare, where they provide the basis for approximately 70% of medical decisions.9
Turn-around-time in drug development and discovery is a critical measurement, enabling progression through to patient use and treatment.
A hospital-attached clinical laboratory operating in 2020 during the pandemic at Brigham and Women’s Hospital in Boston, MA, managed to maintain consistent turn-around-time for collection through to result, despite a steady increase in testing volumes.10 The clinical laboratory division cited they mitigated turnaround time delays through four fundamental actions:
The recruitment of additional staff
Modifications in workflow
The validation of additional rapid testing platforms
Close integration with clinical operations teams
The clinical laboratory’s approach is largely associated with workforce alterations and strengthening, through recruitment, workflow adaptations, and close integration with other on-site teams. While these strategies are only partly achievable through traditional outsourcing solutions, newer scientific services enable organisations to comprehensively strengthen turnaround times through continued close team integration on-site.
In the US, the Clinical Laboratory Improvement Amendments (CLIA) requires that laboratory personnel are adequately trained to not only perform patient specimen testing in a reliable

and accurate way, but problem solve and understand how to proactively address device defects and other issues.11
Promoting, and enabling the wider workforce to develop strong critical thinking skills, all while maintaining technical efficacy can pose huge time constraints for laboratory leaders.
Scientific service models address these challenges by activating employee development programmes for their on-site staff with a focus on continuous improvement and lean methodology, enabling the wider team to advance and improve together.
Administrative chores and routine tasks can consume a large amount of laboratory specialist workers’ time, taking away from core science and limiting the scope of innovation, as well as the opportunity for serendipitous observations, of which are noted by researchers to play a core role in pharmaceutical research and development.12
Time wastage on such tasks can also inadvertently increase turnaround-times in laboratory environments, delaying development and affecting stakeholder engagement in projects.
Innovation is required to address these constraints without adding to the complexities of clinical research, or the workload of managers.
Procedural alignment across laboratory operations, whether

in-house, or through CROs is essential to the accuracy and useability of any data and findings.
The quality systems of the main and any externally used laboratories, must be able to assess and continuously improve service performance and delivery to meet patient needs. This should be accomplished through continuous monitoring to identify, evaluate, and resolve any problems that arise over the course of testing processes.13

Additionally, to achieve comparable results across laboratories, measurement procedures should be completely aligned. This means ensuring the calibration of all measurement procedures to a common reference system, with reference methods and materials, as well as ensuring that all measurement procedures measure the same quantities of these materials.
This process of metrological traceability can be made more complex when working with an outside laboratory and can pose significant consequences when mismanaged. Noncomparable research results can affect the wider research field, making other research findings appear inconsistent, facilitating incorrect conclusions to be drawn.14
Carol Jennings, Synergy Director expands on the importance of working with a trusted collaborator saying, “If you are manufacturing a quality product, or developing a novel entity or compound, you need to trust your staff to preserve that quality through discovery, development, and manufacture.”
To help preserve business continuity, the consistency and comparability of procedures and data, control time wastage, and empower staff to problem solve, new innovative models in scientific services are helping laboratory operations advance, while minimising risk and returning time back to science.
1. Jonathan M Tsai, Nicole V Tolan, Athena K Petrides, et al. How SARS-CoV-2 Transformed the Clinical Laboratory: Challenges and Lessons Learned, The Journal of Applied Laboratory Medicine, Vol. 6, Issue 5, pp. 1338–1354, (2021)
2. https://www.mckinsey.com/industries/life-sciences/our-insights/ pharma-operations-creating-the-workforce-of-the-future, visited on 8th July 2022.
3. https://www.abpi.org.uk/publications/bridging-the-skills-gap-in-thebiopharmaceutical-industry-2022/, visited on 8th July 2022.
4. Bilette de Villemeur et al. Biopharmaceutica R&D outsourcing: Short-term gain for long term pain?, MPRA, (2021)
5. Bilette de Villemeur et al. Biopharmaceutica R&D outsourcing: Short-term gain for long term pain?, MPRA, (2021)
6. Nicholson, S., Danzon, P. M., and McCullough, J., “Biotechpharmaceutical alliances as a signal of asset and firm quality,” Journal of Business, Vol. 78, Issue 4, pp. 1433-1464. (2005)
7. Arora, A., Gambardella, A., Magazzini, L., Pammolli, F., and Riccaboni, M.,“The nature and the extent of the market for technology in biopharmaceuticals,” in: Cesaroni, F., Gambardella, A., and GarciaFontes, W. (eds), R&D, Innovation and Competitiveness in the European Chemical Industry, Springer, pp. 175-202. (2004)
8. Pammolli, F., Righetto, L., Abrignani, S., Pani, L., Pelicci, P. G., and Rabioso, E., “The endless frontier? The recent increase of R&D productivity in pharmaceuticals,” Journal of Translational Medicine, Vol. 18, Issue 1, pp. 162-176. (2020)
9. Kevin C Graden, MS, Shannon A Bennett, MS, MBA, Sarah R Delaney, PhD, Hillary E Gill, BS, Maria A V Willrich, PhD, A High-Level Overview of the Regulations Surrounding a Clinical Laboratory and Upcoming
Regulatory Challenges for Laboratory Developed Tests, Laboratory Medicine, Volume 52, Issue 4, pp. 315–328 (2021)
10. Jonathan M Tsai, Nicole V Tolan, Athena K Petrides, et al. How SARS-CoV-2 Transformed the Clinical Laboratory: Challenges and Lessons Learned, The Journal of Applied Laboratory Medicine, Vol. 6, Issue 5, pp. 1338–1354, (2021)
11. Kevin C Graden, MS, Shannon A Bennett, MS, MBA, Sarah R Delaney, PhD, Hillary E Gill, BS, Maria A V Willrich, PhD, A High-Level Overview of the Regulations Surrounding a Clinical Laboratory and Upcoming Regulatory Challenges for Laboratory Developed Tests, Laboratory Medicine, Volume 52, Issue 4, pp. 315–328 (2021)
12. Bilette de Villemeur et al. Biopharmaceutica R&D outsourcing: Short-term gain for long term pain?, MPRA, (2021)
13. Kevin C Graden, MS, Shannon A Bennett, MS, MBA, Sarah R Delaney, PhD, Hillary E Gill, BS, Maria A V Willrich, PhD, A High-Level Overview of the Regulations Surrounding a Clinical Laboratory and Upcoming Regulatory Challenges for Laboratory Developed Tests, Laboratory Medicine, Volume 52, Issue 4, pp. 315–328 (2021)
14. Hubert W Vesper, Gary L Myers, W Greg Miller, Current practices and challenges in the standardization and harmonization of clinical laboratory tests, The American Journal of Clinical Nutrition, Volume 104, Issue suppl_3, pp. 907S–912S (2016)
Robin Aris is the Associate Director for Synergy, Scientific Managed Services


Web:
May Huxley
Senior Content Writer
Scientific Managed Services









The biologic market has grown expediently over the past few years, driven not only by the pandemic but also by the increasing demand for innovative therapies, the continued rise in chronic disease areas such as oncology and the loss of patent exclusivity of leading biologic drugs. This has led to a rapid growth of aseptic processing which is expected to reach $24.36 billion by 2031, growing from $10.63 billion in 2020, witnessing a CAGR of 7.9% (2021–2031)1
With the pharmaceutical industry’s growing pipeline of biologics, the need for technically advanced manufacturing and specialized packaging support has grown considerably. Global contract development and manufacturing organizations (CDMOs) such as PCI Pharma Services are playing a vital role, stepping in to fulfil industry needs, providing expert capabilities and scalable capacities for the development, manufacture, packaging and supply of these life-changing drug products for patients.
In response to the evolving biologic landscape and as part of PCI Pharma Services’ global strategy to increase our sterile fill-finish capabilities and help alleviate the worldwide capacity shortage for sterile drug manufacturing and packaging, we are continuing to invest and grow our service offering through acquisition and investment in state-of-the-art technology and our people.
In December 2021, PCI Pharma Services acquired Lyophilization Services of New England (LSNE), a premier CDMO headquartered in Bedford, New Hampshire. The acquisition was a key step for PCI, as LSNE expanded the breadth of our services as a global CDMO, building on our expertise in specialty manufacturing, clinical trial supply and pharmaceutical packaging. PCI now offers integrated end-to-end large and small molecule solutions for our clinical and commercial clients, including global manufacturing capabilities in complex formulations, high potency, sterile fill-finish, and lyophilization.
Lyophilization is a common commercially validated process used to address formulation stability challenges and reduce the complexity associated with cold chain logistics for biologics. The use of lyophilization for pharmaceutical drug products has grown over recent years with demand for this process due to increase as more biosimiliars and novel biologics are developed.
Meeting this growing demand, PCI Pharma Services has doubled our large scale lyophilization capacity at our Madison, Wisconsin facility providing a seamless solution to help our clients progress their drug products through the clinical cycle to commercialization and product launch.
Further enhancing our integrated development to commercialization sterile fill-finish offering, we have committed
to over $100 million investment at our Bedford, New Hampshire
campus. This investment will see the construction of a new 50,000ft 2 facility expansion, enhanced capabilities and increased capacity all using state-of-the-art isolator technology including high speed, large volume sterile fill-finish lines with the capacity to fill up to 400 vials per minute.
Administered parenterally to patients, products such as vaccines and other biologics, require specific and unique production processes to optimize both particulate and bioburden control whilst ensuring uncompromised sterility throughout the manufacturing process to maximize patient safety. This has led to the development of aseptic transfer and containment methods to protect drug products from contamination for clinical and commercial scale sterile injectable products.
As a result, the industry is looking for advanced ways of improving efficiency, reducing cost and increasing sterility assurance, with robotic processing gaining huge popularity for the primary filling of Ready to Use (RTU) containers such as vials, syringes and cartridges. Robotic aseptic fill-finish technology and the use of isolator-barrier systems are emerging as key to keeping pace with these requirements, and PCI Pharma Services is leading the way by investing in this cutting-edge technology to further enhance our global sterile fill-finish operations.
Robotic Aseptic Platforms at PCI Pharma Services
Complementing our global sterile fill-finish and lyophilization manufacturing capabilities across North America and Europe, PCI Pharma Services has invested significantly in state-of-theart robotic technology platforms at both our San Diego, US and Melbourne, Australia facilities. These technologies are positioned at locations where a high volume of early phase clinical trials take place and also allow our clients to benefit from the 43% tax rebate incentive for clinical trials conducted in Australia.
Utilizing the latest advancements of the Microcell and SA25 technologies, we deliver flexible aseptic fill-finish solutions for both small and larger-scale production runs across a variety of dosage forms including vials, prefilled syringes and cartridges for use in auto injectors, helping to meet our clients’ needs delivering products to patients safely and efficiently. Our investment in multiple robotic technologies provides a scalable solution for our clients, meeting requirements from smaller Phase I trials through to commercialization and beyond.
The Microcell platforms in San Diego and Australia offer fully automated, gloveless filling, performed through closed robotic isolator technology that provides both small batch flexibility and standardized manufacturing. The fast changeover and agility of the technologies make it suitable for the production of both personalized medicine batches and clinical trial supplies
delivering true speed to patients. Superior drug product quality is assured through advanced automation, removing the need for operator intervention during the filling process and limiting product contact. Importantly, the Microcell technology can fill up to 1,200 units per batch with fill volumes ranging from 1.0 –50mL.

Providing a scalable aseptic solution in support of clients progressing through the clinical lifecycle towards commercialization, the SA25 Aseptic Filling Workstation is a larger-scale, gloveless, isolator-based filling technology offering small and large scale batch production of up to 20,000 units, supporting fill volumes from 0.2–50mL. It provides flexible and standardized manufacturing, and the ability to fill multiple delivery device formats including vials, syringes and cartridges through an aseptic process.
For both the Microcell and SA25 technologies, precise, programmable robotic functions cover all aspects of the fill process, including isolator leakage tests, VHP sterilization of the container closures, filling into the CCS of choice, capping and batch delivery. They are also compatible with RTU containers and closures, removing the container and closure preparation stage, aiding speed of delivery of a quality and sterility assured drug product.
Expediting the filling process with automation while also increasing accuracy, the robotic platforms with high-precision Dynamic Peristaltic Pumps ensure accurate fill volumes with minimal product losses. This is a significant benefit to our clients, who are often developing life-changing, high-value
drug products with the need of progressing through the clinical pipeline with efficiency and speed. Minimizing product losses not only conserves valuable drug product and therefore reduces cost, but ensures our clients clinical supply needs are met and key milestones are achieved as the product progresses towards commercialization.
With a robot performing the processes in a recipe driven, validated system and utilizing single-use parts, pre-sterilized flow paths and RTU containers, multiple sources of risk are eliminated including; cross-contamination, human error, electromechanical filling and closure activity failures, environmental control failures, cleaning and set-up errors; and product loss.
Using press-fit vial closures with integrated rubber stoppers not only reduces the risk of particle contamination but also simplifies the manufacturing process with the press-fit closures being a one-step application that presses closures on top of the vials, versus the traditional two-step process of stoppering and aluminium crimp capping. All this combined means our clients are able to move more rapidly through the clinical stages and provide safe, life-changing therapies to patients.
Robotic technologies are designed for maximum flexibility while maintaining high aseptic processing rates. Meeting the needs to fill many different products and process multiple projects with minimal changeover time between batches, provides ultimate savings in time allowing us to better support clients who have urgent drug product supply needs.
Our clients have the aim of accelerating their sterile drug
development lifecycle and seek readily available capacity, reducing time to clinic and ultimately commercial launch. They seek experienced partners able to meet their fill demands with state-of-the-art technology to minimize the risk of failure particularly in the early-stage development of complex, high value products that by nature can be difficult to handle. Any failure during the aseptic fill-finish process can lead to product degradation affecting a drug’s efficacy and safety. The importance of mitigating risk cannot be overstated: failure in a batch can mean significant time to replace it at substantial cost, and may put the entire timeline in jeopardy, delaying clinical trials, launch plans, commercialization and ultimately impacting patient lives.
The addition of these innovative robotic aseptic fill-finish platforms in our San Diego and Australian facilities enhances our renowned sterile and lyophilization capabilities across our global network. These advanced technologies not only expedite the filling process with automation but being able to pivot between filling different sterile medications into multiple dosage formats, brings even broader sterile fill-finish solutions to PCI clients across the entire drug product lifecycle bringing therapies to market with increased speed and safety.
Providing integrated end-to-end solutions and helping to reduce supply chain complexity and risk, our clients can also access our expert secondary packaging, labeling and distribution solutions available across our extensive global network, leveraging the benefits of with working with a single supplier.
Centers of Excellence for Biologic Packaging Committed to being a market leader in the packaging of biologic products for our global clients, our goal is to help our customers safely and rapidly bring their novel medications to patients. With more than 50 years’ experience and delivering over 90 successful product launches each year, PCI has developed industry leading technical expertise in the end-to-end processing of these often challenging and complex molecules. Our industry insights and expertise enable us to provide biologic packaging solutions that truly differentiate products.
Driven by innovation and the trend towards self-administration and patient-centricity, we offer advanced, flexible packaging solutions for a diverse portfolio of conventional and specialty injectable drug delivery devices. We have the flexible scalability to handle the dynamic volumes of biopharmaceutical therapies, whether large or small, from niche personalized medicines to large-volume treatments.
Complementing our sterile manufacturing investments, we continue to expand our European, North American and UK biologic Centers of Excellence for clinical and commercial packaging. These state-of-the-art facilities are equipped with advanced packaging technologies for the labeling and assembly of vials, cartridges, standard prefilled syringes, advanced safety syringes, autoinjector and pen devices complete with integrated top-load Dividella cartoning and in-line serialization.
Partnerships with leading suppliers such as Dividella, Groninger, Marchesini Group and Syntegon (formerly
Bosch Packaging Technology) and investments in the latest high-speed automatic packaging technologies allows for greater flexibility in serving our customers across their clinical and commercial supply chain requirements for global clinical trials, product launches, global ramp-up, or ongoing market supply.
Supporting the processing of biologic medicines, we maintain a comprehensive cold chain and ultra-cold chain portfolio with temperature ranges including refrigerated (2–8 °C), frozen (–20 °C, –40 °C, –80 °C) and cryogenic (–196°C) for advanced medicinal therapeutic products (ATMPs), including cell and gene therapies.
Meeting the dynamic demands of the marketplace whether it be for sterile process development, scale up, technology transfer or bespoke packaging of biologic drug products, at PCI we provide a collaborative, creative and tailored approach to deliver upon our mission of being the bridge between life-changing therapies and patients. By combining our expertise in sterile fill-finish manufacturing with specialist biologic packaging, labeling and cold chain distribution provides a valuable end-to-end solution, simplifying the supply chain while delivering time and cost efficiencies.
As more new biologically derived therapies such as antibody, mRNA and SRNA treatments are discovered, the need for specialized sterile fill-finish and biologic packaging capabilities and capacities will continue to increase. As the biopharmaceutical industry seeks to reduce the time to market for new therapies and lower the risk associated with high-cost product loss whilst increasing sterility and patient safety, robotic filling and automated packaging platforms will be a true differentiator, offering additional levels of assurance and delivering life-changing therapies as rapidly as possible without compromising product quality or patient safety.
1. Aseptic Pharma Processing Market – Industry Analysis, Trends & Forecast 2031 | BIS Research
Tom McGrath is currently the VP, Global Quality, Manufacturing at PCI Pharma Services, a pharmaceutical full service CDMO. Mr. McGrath has over 25 years of in drug development, quality, and regulatory roles, with the last decade+ focused on aseptically processed pharmaceuticals and medical devices. Prior to assuming his current role in 2014, he was Sr. Director of Quality for Aseptic Services at AMRI–Burlington(now Curia), where he led successful remediation efforts. Before that he held development and quality positions of increasing responsibility at AMAG Pharmaceuticals, CombinatoRx and Praecis Pharmaceuticals. Tom received his B.A. degree in Chemistry from The College of the Holy Cross.






The delivery of therapeutics by inhalation is a medical process dating back thousands of years. The first written evidence of this can be found ca. 1550 BC in Egypt, where vapours of the black henbane plant were used to treat patients with breathing difficulties.1 We now know this vapour likely contained anticholinergic chemicals similar to those now used in modern inhalers to reduce inflammation and bronchoconstriction in the airways.
Despite major advances over the past three millennia in the treatment of pulmonary disease patients with inhaled medications, there is still no single therapy that controls the underlying lung disease, only temporary, symptom management-based approaches. This presents a significant opportunity for the development of novel medications which can be used to treat – and ultimately, cure – diseases that areresponsible for the deaths of approximately 8 million people per year.2
Delivering drugs through the pulmonary route has several benefits. It is non-invasive, with relatively little metabolic activity compared to other therapeutic routes. Our lungs also provide a large, thin surface area with direct access to the whole systemic bloodstream. This means that as well as being the optimal route for drugs directly targeting the lungs, it is also a rapid and simple way to transport drugs to other target organs.

However, the lung presents many hurdles that must be overcome for the successful delivery of a compound to the target cell or bloodstream. Understanding these challenges is key for the design of inhaled medications, not only to ensure drugs are delivered to the site of action, but also that they remain efficacious relative to their role. Current models for measuring the ADME (absorption, distribution, metabolism, excretion) properties of compounds through the lung are limited due to lack of predictivity, high cost and time. However, new human-relevant techniques are emerging which are changing the face of preclinical testing. Organ-on-a-chip (OOC) technology, also known as microphysiological systems (MPS), is a key innovation which can be used to reduce our reliance on traditionally used animal testing, by providing a physiologicallyrelevant and clinically translatable model that is both time and cost effective. Engaging with these new technologies will allow more analytical and rapid understanding of the multi-faceted journey of inhaled medications.
The first, and potentially most inhibitory challenge in a drug’s ability to deliver results is the physical act of inhalation from the device into the patient’s lungs. At this stage, a high proportion of the drug can already be lost due to poor technique, including lack of shaking the inhaler, or poor inhalation, which can lead to drug being swallowed rather than inhaled into the lungs. Recent innovations in inhaler technology, including spacers and even
smart inhalers connected to smart phones, have enabled more effective medication delivery to tackle this initial inefficiency.3
The next challenge is understanding where, in the lungs, a particle will be deposited. Ultimately, this depends on its size and chemical properties. Smaller particles will be deposited into the distal lung (smaller bronchioles and alveoli) whereas larger, heavier particles will deposit in the proximal lung (trachea and bronchi). Therefore, if the drug is designed to target bronchial function – such as a bronchodilator – then a larger particle (>5 µm diameter) will be advantageous, whereas if the drug is designated to act elsewhere in the body – such as insulin – the particle size should be smaller (1–5 µm) to allow it to reach the alveoli and then bloodstream. Any particle less than 1 µm would likely not be dense enough to settle and would instead be suspended in the air and exhaled.
Depending on where the drug lands along the pulmonary tree, the next influencing step is the dissolution of the drug into lung fluid. In the airways, a 10 µm layer of viscous liquid covers the epithelium, the top layer of which is a gel-like layer of mucus. Any inhaled molecule therefore needs to dissolve and diffuse through these layers before being absorbed by cells. At this rate-limiting step, the drug is at risk of being eliminated from the lung by mucociliary clearance. Cells in the epithelium contain cilia on their cell surface which rhythmically beat, moving the mucus layer up and out of the airways. This is a good system for clearing unwanted invaders from the lung,

Figure 2. ADME routes of inhaled medications through the body. Drug is inhaled into the lungs where it absorbs into the bloodstream and distributes around the body. It is then metabolised by the liver and excreted.

such as environmental particles or pathogens, however not so useful for drug delivery.
In contrast to other regions of the lungs, if a drug reaches the alveoli, there is no mucus or ciliary bodies to inhibit its journey to the epithelium. The alveolus is an extremely thin (0.1–0.3 µm) cell barrier with a small layer of non-sticky, immobile liquid. Therefore, in comparison to the thick bronchial airways, the alveolar passage is (on paper) an easier way of gaining access to the bloodstream. However, alveoli do contain alveolar macrophages, the resident immune cell within the lung, that patrol around the 500 million alveoli, engulfing any foreign material they come across. Alveolar macrophages will engulf and try to digest drug compounds, however, any that are indigestible can remain sequestered within lung macrophages for years.

Taken together, the quicker an inhaled medication can dissolve into the lung fluid the more likely it is to reach its target before being eliminated or sequestered. So which drug type is best placed? One would assume a highly water-soluble (hydrophilic) molecule would quickly dissolve into fluid and reach the epithelium. However, a hydrophilic molecule, once it reaches the cell surface, will not absorb as rapidly into cells. In a rat model study comparing compounds with a range of chemical properties, it was broadly found that hydrophilic molecules have an absorption half-life into the lung of around 60 minutes.4 Lipophilic compounds, which do not dissolve well in aqueous solutions but will interact with lipids – like those in the cell membrane – were found to have a lower half-life of around 60 seconds.
Most drugs require absorption into or across the epithelium to reach their site of action. The permeability of the barrier is influenced by several factors such as the thickness of the epithelium, cellular phenotype, the number of intercellular junctions and types of transporters expressed on the cell surface. 5 Molecules can move, or be moved, across the lung epithelium in several manners. Very small hydrophilic compounds can travel passively through the junctions
between cells – this is called the paracellular route. Small lipophilic molecules can passively diffuse through cells via their interaction with the cell lipid membrane – the transcellular route. Accordingly, these small molecules are absorbed quickly, as described previously.
In some cells, particularly alveolar type I cells, drugs can be transported across and into the endothelium via vesiclemediated mechanisms. The drug is encapsulated by an extension of the cell membrane and is brought into the cell interior as a vesicle, which is then transported across the cell and deposited in the opposite manner from the cell membrane on the endothelial side. Larger or more complex compounds can be actively transported across cells using specific protein transporters (e.g., organic cation transporters OCT-1). Transporters are expressed at different levels on specific cell types within the lung, which affects the rate a drug may be transported in particular sections of the lung.6
Whilst transiting the epithelium, certain drugs can become “trapped” within cells in vesicles, mitochondria or lysosomes due to the lower pH inside cells. Non-ionised, basic drugs (usually lipophilic) which enter the cell easily are protonated by the more acidic environment, and thus unable to diffuse back across the cell membrane. Highly lipophilic drugs may also become sequestered in the cell membrane, resulting in longer retention within the lung.
Overall, despite the lung being a relatively simple and rapid way to administer drugs, careful consideration must be given to the chemistry of the drug with respect to the requirements of time of onset, longevity and organ-targeting. The ‘correct’ chemistry of the drug can be predicted, however only until it is tested in a biological system can the full implications of the chemistry be understood.
The challenges described for designing a drug for pulmonary administration result from the complex biology and physiology of the human lung. Currently, drugs are required to be tested on animals for preclinical testing, particularly for toxicity testing. This includes mice, rats, rabbits, dogs and non-human primates, which are exposed either in whole-body tubes (small rodents) or are restrained and exposed through head or mouth pieces (larger mammals). However, there are many differences between human and animals respiratory tracts, including lung anatomy (architecture and cell type distribution), physiology (manner and rate of breathing), immunology (cell types and distribution) and biology (expression of transporters and enzymes).7 This diversity has resulted in an extremely

Supporting your small and large molecule aseptic fill & finish needs, we have a wealth of experience providing contract sterile filling to our customers around the world. We’ve got the capacity and ingenuity to solve your problems in fill & finish of biologics such as vaccines, as well as your small molecule products.
Experience the problem solving power of our people, and discover the genius of working together.
high attrition rate of pulmonary medications, with only 3% of drugs reaching the market compared to 6–14% for other disease therapeutics. 8 As testing in vivo can take many years and millions of dollars, the current investment in drug development is very risky.9,10
However, more than ever before there is a clear desire by regulatory agencies to reduce the requirement for animal testing by using new alternative methods (NAMs) such as advanced in vitro models, systems biology and mathematical modelling. This year, the US House of Representatives passed the FDA Modernisation Act which aims to reform the drug approval process by driving the use of NAMs.11
Traditional in vitro models of cultured lung cell lines are not best placed for this replacement. Cell lines such as Calu-3, 16HBE14o- (bronchial) and A549 and NCI-H441 (alveolar) have been used for a variety of applications. However, despite them each being able to mimic an aspect of lung biology, they are not able to replicate the full depth and complexity of the complete human organ. As an example, in air-liquidinterphase cultures Calu-3 can form a cell layer and secrete mucus, so can be useful for the study of dissolution of drugs. However, there are disparate reports of cilia production ability (or lack thereof) and responses to stimuli.12,13 Without the full spectrum of bronchial cell phenotypes, translating the results of a drug study from cell line cultures to patient outcomes can become challenging.
Recently, more sophisticated models of in vitro cell culture have been employed. The increased availability of primary and stem cells has allowed production of more human relevant cultures. Use of OOC/MPS technologies further enhance the physiological relevance of primary or stem cell cultures by replicating the human lung microenvironment through media perfusion to mimic blood flow, stretch conditions and the inclusion of multiple lung cell types.14 Multiple MPS models
are now available that recapitulate the airways or alveoli. They demonstrate more relevant lung anatomy through the inclusion of relevant cell types, functionality (such as production of mucus or surfactant) and physiologically relevant permeability, thus allowing more informed decision making about the safety and efficacy of a therapeutic.

So how can these novel approaches replicate the intricacies of pulmonary drug delivery to predict outcomes in preclinical testing? A collective, multi-disciplinary approach will be crucial. By combining lung MPS cultures and anatomically accurate drug impactor technologies the biological relevance of in vitro exposures can be maximised. 15,16,17 These novel engineering and bioengineering technologies can be combined or used independently to understand a variety of factors, including deposition, rate of absorption and permeabilisation of drugs through the lung epithelium, toxicity and pharmacology.
A selection of MPS providers offer the ability to link different organ MPS together into multi-organ systems that allow organ-crosstalk studies, for example to understand the metabolism of drugs by the liver, or interactivity of immune cells between organs.18,19,20 Technologies that offer recirculating fluidic flow, designed to mimic the bloodstream, also enable components of the immune system to be incorporated into lung MPS models. This enables the study of immune interactivity between organs or specific immune responses to drugs. As many new drugs are based on immune-based therapies, these areas are becoming increasingly important to understand and reliably test in the preclinical stages.
A good example of where in vitro MPS offer clear advantages over in vivo testing is the understanding of inhaled drug deposition and dissolution. As previously mentioned, animals, such as mouse, have a significantly different lung
physiology and biology to humans21 As well as these obvious disparities, practically measuring deposition and dissolution in animal models is challenging, and often requires an animal to be sacrificed at regular timepoints to obtain tissues which are subsequently analysed for drug abundance. As well as a distinct waste of animal life, it is extremely costly and time-consuming.
Furthermore, understanding the exact localisation of a drug is problematic in animal models. Upon isolation of tissue, often the whole lung tissue is homogenised for analysis, meaning drug concentration differences between lobes, areas and cell layers are undistinguishable.22 In vitro studies using MPS and aerosolisation technologies not only allow human relevant drug exposures, but are also able to detect precise drug localisation, receptor specificity, absorption in cells and permeability through the barrier over time. Drug accumulation and release can be monitored over longer periods of time by repeated sampling in the same culture, making for more cost-effective testing which can be replicated both technically and biologically. Different cell donors can also be used in MPS
to generate a “clinical trial-like” study to understand reactions of people of different genders, ethnicities, ages and disease states.
Over the past decade, development of MPS technologies has accelerated to the point where many different options are available for drug developers and regulators to evaluate. Their focus should now be firmly set on how these in vitro systems can best replace, or at the least reduce, animal testing in terms of i) predictivity ii) biological relevance iii) ability to test different parameters iv) ease of use v) cost and vi) turnaround for fast-track decision making earlier in the developmental pipeline. Regulators such as the FDA and the European Medicines Agency (EMA) will be key players in the adoption of NAMs for use in ADME and toxicology studies, and many have already begun to evaluate these systems for use in predictive preclinical studies.
In summary, the pulmonary route of drug delivery is a route vastly unappreciated and under-utilised. There are a plethora of applications for inhaled medications which are not limited

to pulmonary diseases. However, with the rise of respiratory diseases from environmental pollution and novel pathogens (such as SARS-CoV-2), rapid development of pulmonary medications will inevitably be required. Current preclinical animal models are clearly not sufficiently predictive of human responses, as evidenced by high drug attrition rates, therefore novel methods, such as MPS, must be brought to the forefront. The adoption of these state-of-the-art techniques will not only save countless animal lives, researcher time and money, but also revolutionise and accelerate drug development, to better the lives of millions of patients.
1. Stein, S. W., & Thiel, C. G. (2017). The History of Therapeutic Aerosols: A Chronological Review. Journal of Aerosol Medicine and Pulmonary Drug Delivery, 30(1), 20. https://doi.org/10.1089/ JAMP.2016.1297
2. WHO. (2020). WHO Global Health Estimates. https://www.who. int/news-room/fact-sheets/detail/the-top-10-causes-of-death
3. Sorino, C., Negri, S., Spanevello, A., Visca, D., & Scichilone, N. (2020). Inhalation therapy devices for the treatment of obstructive lung diseases: the history of inhalers towards the ideal inhaler. European Journal of Internal Medicine, 75, 15–18. https://doi. org/10.1016/J.EJIM.2020.02.023
4. Patton, J. S., Fishburn, C. S., & Weers, J. G. (2004). The lungs as a portal of entry for systemic drug delivery. Proceedings of the American Thoracic Society, 1(4), 338–344. https://doi. org/10.1513/PATS.200409-049TA
5. Enlo-Scott, Z., Swedrowska, M., & Forbes, B. (2021). Epithelial permeability and drug absorption in the lungs. Inhaled Medicines: Optimizing Development through Integration of In Silico, In Vitro and In Vivo Approaches, 267–299. https://doi.org/10.1016/ B978-0-12-814974-4.00004-3
6. Nickel, S., Clerkin, C. G., Selo, M. A., & Ehrhardt, C. (2016). Transport mechanisms at the pulmonary mucosa: implications for drug delivery. Https://Doi.Org/10.1517/17425247.2016.1140144, 13(5), 667–690. https://doi.org/10.1517/17425247.2016.114 0144
7. Clippinger, A. J., Allen, D., Jarabek, A. M., Corvaro, M., Gaça, M., Gehen, S., Hotchkiss, J. A., Patlewicz, G., Melbourne, J., Hinderliter, P., Yoon, M., Huh, D., Lowit, A., Buckley, B., Bartels, M., BéruBé, K., Wilson, D. M., Indans, I., & Vinken, M. (2018). Alternative approaches for acute inhalation toxicity testing to address global regulatory and non-regulatory data requirements: An international workshop report. Toxicology in Vitro, 48, 53–70. https://doi. org/10.1016/J.TIV.2017.12.011
8. Barnes, P. J., Bonini, S., Seeger, W., Belvisi, M. G., Ward, B., & Holmes, A. (2015). Barriers to new drug development in respiratory disease. In European Respiratory Journal (Vol. 45, Issue 5, pp. 1197–1207). European Respiratory Society. https:// doi.org/10.1183/09031936.00007915
9. Meigs, L., Smirnova, L., Rovida, C., Leist, M., & Hartung, T. (2018). Animal testing and its alternatives – the most important omics is economics. ALTEX - Alternatives to Animal Experimentation, 35(3), 275–305. https://doi.org/10.14573/ALTEX.1807041
10. Van Norman, G. A. (2019). Limitations of Animal Studies for Predicting Toxicity in Clinical Trials: Is it Time to Rethink Our Current Approach? JACC: Basic to Translational Science, 4(7), 845–854. https://doi.org/10.1016/J.JACBTS.2019.10.008
11. Express Pharma News Bureau. (2022, June 9). US House passes legislation to end FDA animal testing mandate – Express Pharma. https://www.expresspharma.in/us-housepasses-legislation-to-end-fda-animal-testing-mandate/?utm_ content=211126300&utm_medium=social&utm_ source=linkedin&hss_channel=lcp-1375042
12. Grainger, C. I., Greenwell, L. L., Lockley, D. J., Martin, G. P., & Forbes, B. (2006). Culture of Calu-3 cells at the air interface provides a representative model of the airway epithelial barrier.
Pharmaceutical Research, 23(7), 1482–1490. https://doi. org/10.1007/S11095-006-0255-0/FIGURES/3
13. Martens, K., Hellings, P. W., & Steelant, B. (2018). Calu-3 epithelial cells exhibit different immune and epithelial barrier responses from freshly isolated primary nasal epithelial cells in vitro. Clinical and Translational Allergy, 8(1), 1–4. https://doi.org/10.1186/ S13601-018-0225-8/FIGURES/2
14. Dellaquila, A., Thomée, E. K., McMillan, A. H., & Lesher-Pérez, S. C. (2020). Lung-on-a-chip platforms for modeling disease pathogenesis. Organ-on-a-Chip: Engineered Microenvironments for Safety and Efficacy Testing, 133–180. https://doi.org/10.1016/ B978-0-12-817202-5.00004-8
15. Jeannet, N., Fierz, M., Kalberer, M., Burtscher, H., & Geiser, M. (2015). Nano Aerosol Chamber for In-Vitro Toxicity (NACIVT) studies. Http://Dx.Doi.Org/10.3109/17435390.2014.886739, 9(1), 34–42. https://doi.org/10.3109/17435390.2014.886739
16. Steiner, S., Herve, P., Pak, C., Majeed, S., Sandoz, A., Kuczaj, A., & Hoeng, J. (2020). Development and testing of a new-generation aerosol exposure system: The independent holistic air-liquid exposure system (InHALES). Toxicology in Vitro, 67, 104909. https://doi.org/10.1016/J.TIV.2020.104909
17. Zhang, J., Doshi, U., Wolz, R. L., Kosachevsky, P., Oldham, M. J., Gillman, I. G., & Lee, K. M. (2022). Fit-for-purpose characterization of air-liquid-interface (ALI) in vitro exposure systems for e-vapor aerosol. Toxicology in Vitro : An International Journal Published in Association with BIBRA, 82. https://doi.org/10.1016/J. TIV.2022.105352
18. Chen, W. L. K., Edington, C., Suter, E., Yu, J., Velazquez, J. J., Velazquez, J. G., Shockley, M., Large, E. M., Venkataramanan, R., Hughes, D. J., Stokes, C. L., Trumper, D. L., Carrier, R. L., Cirit, M., Griffith, L. G., & Lauffenburger, D. A. (2017). Integrated gut/liver microphysiological systems elucidates inflammatory inter-tissue crosstalk. Biotechnology and Bioengineering, 114(11), 2648–2659. https://doi.org/10.1002/BIT.26370
19. Trapecar, M. (2022). Multiorgan microphysiological systems as tools to interrogate interorgan crosstalk and complex diseases. FEBS Letters, 596(5), 681–695. https://doi.org/10.1002/18733468.14260
20. Tsamandouras, N., Chen, W. L. K., Edington, C. D., Stokes, C. L., Griffith, L. G., & Cirit, M. (2017). Integrated Gut and Liver Microphysiological Systems for Quantitative In Vitro Pharmacokinetic Studies. AAPS Journal, 19(5), 1499–1512. https:// doi.org/10.1208/S12248-017-0122-4/FIGURES/8
21. Irvin, C. G., & Bates, J. H. T. (2003). Measuring the lung function in the mouse: The challenge of size. Respiratory Research, 4(1), 1–9. https://doi.org/10.1186/RR199/FIGURES/6_195
22. Forbes, B., Asgharian, B., Dailey, L. A., Ferguson, D., Gerde, P., Gumbleton, M., Gustavsson, L., Hardy, C., Hassall, D., Jones, R., Lock, R., Maas, J., McGovern, T., Pitcairn, G. R., Somers, G., & Wolff, R. K. (2011). Challenges in inhaled product development and opportunities for open innovation. Advanced Drug Delivery Reviews, 63(1–2), 69–87. https://doi.org/10.1016/J. ADDR.2010.11.004
Dr. Emily Richardson is a Lead Scienist in the R&D department at CN Bio Innovations. Here, she has developed lung and lung-liver MPS models for applications in COVID-19 research and predicting ADME properties of inhaled medications.
Richardson previously worked at Adaptimmune, a leading T-cell therapy company, and received her doctarate from the University of Leicester in Molecular and Cellular Biology.

Richter-Helm is a Germany-based GMP manufacturer specialized in products derived from bacteria and yeasts, with a proven 30-year track record.

Count on us to flexibly provide a comprehensive range of services and customized solutions. Clients worldwide have already benefited from our commitment to good manufacturing practice and total transparency. Our work fo cuses on recombinant proteins, plasmid DNA, antibody fragments, and vaccines.
consistently works to the highest standards of pharmaceutical quality.
The development of lyophilised products helps reduce the impact of cold chain management from refrigerated warehouse to point use. These products, typically, benefit from lower shipping costs, simplify product use, and provide a longer shelf life within the diagnostics, biologics, pharmaceuticals and nutraceutical industries.
Recently, we have seen a trend-shift from traditional lyophilised cakes to lyophilised reagent beads, also known as ‘lyobeads’, which are spheres of customisable, lyophilised material. Unlike traditional lyophilised formats, each individual bead contains a single, accurately measured dose of a precise formulation. These single-dose beads – like all lyophilised material – retain long-term stability at ambient temperature and therefore do not need expensive cold chain shipping or refrigeration during storage.
Lyophilised beads also present further performance and efficiency opportunities,1 particularly in terms of assay accuracy, speed and ease of process:


• Accuracy – lyophilised beads contain a single, precisely measured dose, minimising the potential for variance.
• Cost savings through improved efficiency – with less risk of user errors, a longer shelf life, and less exposure to moisture, wastage is significantly reduced, saving time and money.
• Quick and simple – lyobeads reconstitute quickly due to their volume to surface area ratio and come pre-packaged, ready for immediate use.
The process of manufacturing lyobeads requires a high level of expertise as it starts with the creation of a custom lyophilised bead which is stable and suitable for large scale manufacture. This is usually achieved by use of a Freeze Drying Microscope (FDM)2 to understand the critical temperatures for primary drying phase of the freeze drying cycle. In conjunction with the FDM, the use of a Differential Scanning Calorimetry (DSC) or Lyotherm (DTA & impedance analyser)3 will provide thermal analysis to ensure product stability throughout the and lyophilisation process and future storage conditions. The final process for scale up and manufacturing, is the quality control assessment of lyobeads to meet the required standards for appearance, size and successful drying.
Primary quality control processes for lyobeads include residual moisture content measurement, visual appearance, dissolution rate, assay sensitivity and physical properties. Of these processes, lyobead properties – ultimate tensile strength (maximum strength a bead can withstand before breaking) and friability (how easily the beads can break into smaller parts under duress) – can be best assessed by the MicroPress, a mechanical properties analyser, in a simple non-destructive manner where analysis and quality of the data is independent
of the subjective experience of the operator. The precise dosage measurements within the lyobeads was mentioned earlier as a key differentiator between lyobeads and lyocakes, therefore in the lyophilised format it is paramount to ensure the full product is intact for final use. The lyobeads, during storage, will typically be held within a secondary container and by its nature move within the receptacle, it is therefore imperative that it is manufactured to sustain these movements particularly during shipments.
The MicroPress is an innovative instrument designed and developed by Biopharma Group’s instrumentation specialists to quantify in-situ microscopic defects within low density materials and, specifically, in all freeze dried products to provide pivotal data as to whether or not the products produced have the proper physical characteristics. The MicroPress can quantitively determine the strength and physical robustness of lyobeads and lyocakes in-situ. With set parameters and analysis methods, the MicroPress will be able to analyse the freeze dried product structure. This allows for fast and effective batch screening to be applied to your products, especially when time and resources costs are at a premium; with a standard method the analysis can be completed in less than one minute per freeze dried product.

Stress and strain are two physical quantities commonly used to describe mechanical properties of solid materials.
• STRESS is the tensile or compressive loading (force applied)
• STRAIN is the amount of deformation at distinct intervals.
The relationship between the stress and strain that a particular material displays, is known as that material’s STRESSSTRAIN CURVE (see below):

material. Compared with most materials that are tested for Young’s Modulus (stress-strain), lyophiles, in which lyobeads are included, have results that are VERY light and VERY flexible (see below) and are therefore at the extreme end of the Young’s modulus spectrum:

Use of the MicroPress to assess the elasticity and strength of lyobeads provides quantitative data, which can be diagnostic in nature, to help confirm the best formulation and quality control across batches and for friability testing.

The MicroPress uses an indenter which is lowered down by the use of a programmable actuator (Figure 6) to apply determined pressure onto the sample. The sample is located on a loadcell which will measure the stress being applied to the sample prior to failure. The results are transferred via proprietary software to Excel where the Young’s modulus can be obtained for comparison values.
For purposes of example, see below some experimental results looking at the lyobead appearance, storage and strength:
Through the examples and data shown, before it can be seen that lyobeads add value to the established lyophilisation techniques for storing in bulk pior to packaging, it must be determined that surface area provides better reconstitution rates, each bead is a measured dosage and that the lyobeads a robust enough to withstand handling processes through packaging and shipment procedures. This vial component of the
In this curve, we can identify a useful term, the “Young's modulus”, which is also known as the Modulus of Elasticity (E); this describes the tensile elasticity (or stiffness) of a solid

drying
within their

with
the strength of the product without


use of invasive techniques. With these indicators
cycles
be increased, leading to larger quantity
lower batch rejection
One significant change, that will be immediately clear, is that the event has been rebranded as CPHI Frankfurt and the onsite experience enhanced for attendees’ ease of navigation. For example, the collocated events have been replaced by descriptively named zones for packaging, outsourcing, machinery and more.
“One of the reasons behind the new identity is that we wanted to deliver the smoothest possible onsite experience so that attendees and exhibitors can concentrate on maximising opportunities. Everything we have done is to help the industry to match with exactly the right partners and to be able to do this more quickly,” Orhan Caglayan, Group Director CPHI Frankfurt.
Who Attends: It’s truly the heart of pharma with participants from over 145 countries; with 78% having purchasing responsibility and 47% from the C-suite.
CPHI Frankfurt has been designed to empower attendees to more connections and make them count, with a full platform of enhancing digital tools to use pre-event.
Who Exhibits: CPHI Frankfurt is the beating heart of the entire global pharma/biotech supply chain – with everything from ingredients and finished dosage drugs to machinery, outsourcing providers, packaging and even bioprocessing at BioProduction.
CPHI Awards 2022: Held on 1st Nov 2022, the CPHI Awards will feature a welcome reception and ceremony to celebrate the industry’s achievements and brightest stars – with categories spanning a total of 10 awards.
Event Opening Hours: 10:30am to 6:30pm
Early Access: 9:30am to 6:30pm
VIP Access: 9:30am to 6:30pm
To register kindly visit: https://registration-smartevents.iiris.com/CPHI%2F2022
Connect to Frankfurt: Take the first digital step on your journey to CPHI Frankfurt
Connect to Frankfurt marks the launch of the digital platform – a companion to CPHI Frankfurt – the online meeting place to connect with the entire supply chain. The platform empowers visitors to source suppliers, browse the exhibitors list and discover the full content agenda. Attendees can make contact online, pre-vet partners and then schedule in person meetings at the event.
The CPHI Frankfurt app provides both attendees and exhibitors with a timetable of each day’s activities, a full list of exhibitors and onsite navigation (including hall locations).
CPHI Frankfurt content experience begins online on 28 September 2022, with Connect to Frankfurt. Highlights include a ‘trends outlook’ session hosted by leading marketing intelligence companies (including IQVIA and Accenture), the CPHI Learning Labs – with insights from leading pharma companies on new products & solutions – and an overview of the German pharma market and the CPHI Award finalists.
The on-demand webinars will span more than 40 sessions and cover all topics from ingredients to clinical trials.
A session on ‘Sustainability Strategies in the Life Sciences Industry’ will be hosted by Accenture AG, as well as analysis from GlobalData exploring ‘Predictions for Future Drugs’.
CPHI Frankfurt (1–3 Nov 2022) Content Agenda – The First Full Schedule of In-person Content Since 2019
The conference agenda, the largest ever put together by CPHI, will span some five tracks across three days in the main Conference theatre, with an additional theatre dedicated to ‘Product Innovation and Sustainability.
Running alongside CPHI Frankfurt content will be 3-days of biologics sessions curated by the team at BioProduction. In total BioProduction will feature some 30+ talks covering all aspects of the biologics supply chain from automation and digital to downstream and upstream processing.
Day 1: The first day discusses innovative technologies and latest machine trends that are driving the manufacturing of biologics. A session on how to obtain better data with digitalisation is followed by a session after lunch on faster scale up by ‘Leveraging Wireless 3D Sensor Technology’ hosted by the CEO of Freesense Aps. The day closes with a session on Digital twin assisted manufacturing from Novasign.
Day 2: Under the track Upstream manufacturing the sessions focus on cell culture media improvements and bioreactor characterisation. Two sessions later in the day provide detailed insights into the digital twin assisted manufacturing of continuous mAB and for accelerating timelines.
Day 3: In Downstream and Novel Modalities track there are sessions on use of semi automation for production of ruby specific antibodies and challenges during polishing chromatography for GMP manufacturing. The day ends with an interesting seminar addressing challenges in manufacture of vaccines.
Track 1: Modern Vaccine Platform Technologies
Track 2: Vaccine CMC, Analytical & Process Development
and
Track 2: Applications of Vaccines in Therapeutics



Vaccine Optimisation



Target Purification
Scale-Up Development
Analytical Development
Safety Testing
Antigen Manufacturing

Vaccine Delivery Agents
more information
www.oxfordglobal.co.uk/cell-series-uk/
Harry Liddiard

Italy
see the return of the Clinical Trial Supply Europe conference to Milan

pharma, large and small,
have the opportunity
discuss, debate and consider
processes
never been a better time to exchange case studies, meet

distanced thought leaders,

latest solutions
exhibitors
clinical supply chain.
selection
two-day in person event for industry leading updates on a series of topics around temperature-controlled
how to avoid excursions, using data
monitor temperatures,
products at deep frozen
how your peers
with new Brexit regulations
the supply chain
and out
Page 33 Almac Group
Page 19 Autoscribe Limited
Page 15 Biotech i Kungsbacka AB
Page 54 Cell UK / Oxford Global
Page 41 Charge Point Technology
Page 55 CLINICAL TRIAL SUPPLY EUROPE 2023 / Arena International
Page 53 DDL 2022
BC FUJIFILM Wako Chemicals USA
IBC GenXPro GmbH
Page 9 Life Science Austria

Page 29 Medicilon
Page 31 Nemera
Page 23 Owen Munford Ltd.
Page 5 OXGENE
Page 39 PCI Pharma Services
Page 49 Phage Consultants
Page 7 Precision for medicine
Page 17 Qualogy Ltd
Page 43 Recipharm AB
Page 47 Richter-Helm Biologics GmbH & Co. Kg
IFC RGCC Group / Welmedis Group
Page 13 SGS
Page 3 SPL Scientific Protein Laboratories
Page 55 TCL IN BIOPHARMACEUTICALS EUROPE 2023 / Arena International
Page 35 UPC Cambridge
Page 54 Vaccines Europe / Oxford Global




Testing for microbial contamination
and its raw materials.
Detection of fungal compounds in pharmaceuticals, medical devices, biologics, and genetically engineered products.

Investigation of bacterial pollutants in commercial water.
Study of the structure-activity relationship, biosynthesis, metabolism, and etiological significance of PG.